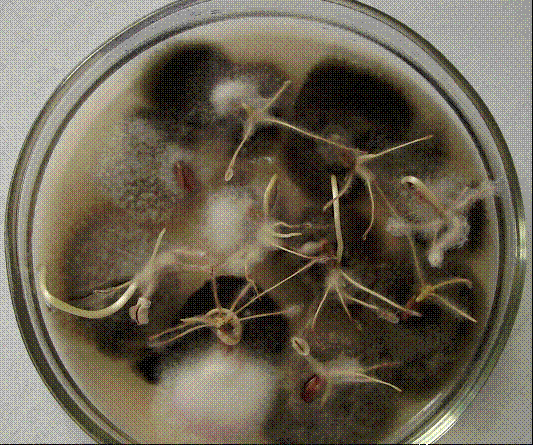

Влияние комплексных удобрений на агроценоз яровой пшеницы и фитосанитарное состояние почвы в условиях Новосибирского Приобья
Оглавление
Введение
. Обзор
литературы
1.1 Значение применения сложных удобрений
в Агро экосистемах
1.2 Микроорганизмы почвы и действие на них сложных удобрений
1.3
Фитосанитарный эффект применения органо-минеральных удобрений
2. Характеристика
места и условий проведения исследований
2.1
Природно-климатические условия зоны
2.2
Специализация хозяйства и экономическая характеристика состояния производства
2.3 Погодные условия лет
исследования
3. Объекты
и методы исследований
3.1
Объекты исследований
.2
Методы исследования
4. Результаты
исследований
4.1
Влияние комплексных удобрений на урожайность яровой пшеницы
4.2.
Влияние комплексных удобрений на микрофлору почвы
.3
Фитосанитарный эффект от применения комплексных удобрений
4.4
Фитосанитарное состояние почвы на фоне сложных удобрений в последействии
5. Экономическое
обоснование
5.1 Составление и расчет технологической карты
5.2
Планирование затрат на производство яровой пшеницы
5.3 Расчет показателей экономической эффективности яровой
пшеницы
6. Экологическое
состояние природной среды в районе исследования
Выводы
и предложения производству
Список
использованной литературы
Приложения
Введение
Применение органических и минеральных удобрений - одно из
основных условий повышения урожайности сельскохозяйственных культур, а также
важное звено технологий их выращивания. Это связано с тем, что само
функционирование агроэкосистемы основывается на систематическом отчуждении
больших количеств биогенных элементов. Так, с 1 т урожая различных
сельскохозяйственных культур из почвы выносится 17-67 кг азота, 1-27 кг
фосфора, 2-114 кг калия (Агроэкология, 2000). Использование удобрений позволяет
возвращать в круговорот изъятые элементы и обеспечивает устойчивую высокую
урожайность и хорошее качество растениеводческой продукции. В настоящее время в
странах с развитым сельским хозяйством за счет удобрений получают до 60% урожая
сельскохозяйственных культур. Проблема компенсации элементов питания в почвах
актуальна и для России (Гамзиков, 1981; Минеев, 1990).
Применение удобрений меняет условия обитания микроорганизмов
в почве. Ее микробное сообщество выполняет функцию поддержания гомеостаза почв,
поэтому быстро реагирует на изменения в среде обитания. Считают, что
микроорганизмы являются хорошим биоиндикатором: они играют ведущую роль в
круговороте азота, лимитирующего продуктивность большинства наземных экосистем,
микробным популяциям присущи специфические особенности (Звягинцев, 1987).
В литературе накоплен достаточно обширный материал,
указывающий на значительные изменения в микробном ценозе почв даже при разовом
внесении минеральных и органических удобрений. Длительное же применение
минеральных удобрений приводит к глубоким изменениям структуры комплекса
почвенных микроорганизмов, изменению соотношения численности физиологических
групп микроорганизмов, участвующих в различных микробиологических процессах и
обеспечивающих плодородие почвы. Как правило, снижается численность
аммонификаторов, сапрофитных грибов, актиномицетов. Кроме этого меняется
видовой состав микромицетов, начинают преобладать виды, относящиеся к родам Penicillium, Trichoderma, Fusarium, способные вырабатывать
токсические вещества. При систематическом внесении высоких доз минеральных
удобрений отмечено повышенное накопление в почве фитотоксических
микроорганизмов (Мишустин, 1972; Минеев, 1990; Артамонова, 2002 и др.).
Негативное влияние возрастающих доз минеральных удобрений
снижается при их совместном внесении с органическими удобрениями в самых
различных формах (навоз, сидераты, солома, перегной, торф). Увеличивается
численность микроорганизмов, обеспечивающих необходимый уровень эффективного
плодородия (аммонификаторы, азотфиксаторы), повышается активность ферментов,
уменьшается фитотоксичность почвы, создаваемая микроорганизмами (Агрохимия,
1989).
Применение сложных удобрений пролонгированного срока действия
можно отнести к перспективным приемам, решающим задачу успешного сочетания
интенсификации земледелия и его экологизации. Постепенное высвобождение из их
состава минеральных элементов препятствует вымыванию азота за пределы
корнеобитаемого слоя и фиксации почвой подвижного фосфора, что важно как для
формирования урожая, так и для экологии. В последние годы интерес к таким
удобрениям в мировой сельскохозяйственной практике существенно возрос, особенно
к сложным комплексным удобрениям, объемы их применения в мире неуклонно растут
(Пироговская, 2004). В своем составе сложные удобрения содержат макро- и
микроэлементы, а также добавки биологически активных веществ, и обладают
полифункциональным действием. Комплексность состава удобрений обеспечивает
более благоприятные условия для роста и развития растений, а добавка гуминовых
элементов, содержащихся в некоторых из них, способствует более эффективному
усвоению питательных элементов из удобрений и почвы.
Одновременно такие удобрения способны влиять и на иммунные
свойства культурных растений. Сведения об оздоравливающем или, наоборот,
усиливающем заболеваемость яровых зерновых культур действии удобрений в
литературе связывают с их непосредственным влиянием на патоген или с
опосредованной активизацией почвенной микрофлоры (Дурынина и др., 1980;
Черняева и др., 1986; Чулкина и др., 1995).
Цель данной дипломной работы - изучить влияние комплексных
удобрений на агроценоз яровой пшеницы и фитосанитарное состояние почвы в условиях
Новосибирского Приобья.
Задачи исследования:
· выявить хозяйственную и экономическую
эффективность применения комплексного гранулированное бесхлорного удобрения ОМУ
«Пшеничное» и удобрения для внекорневой подкормки Акварин 5;
· проследить за изменениями в микробном
ценозе выщелоченного чернозема при применении удобрений;
· изучить фитосанитарное воздействие
комплексных удобрений на заболеваемость растений корневой гнилью;
· оценить последействие комплексных
удобрений на фитосанитарное состояние почвы.
1.
Обзор литературы
1.1 Значение применения сложных удобрений в Агро
экосистемах
В практике аграрного производства
критерием успешного хозяйствования принято считать величину урожайности
сельскохозяйственных культур. Однако, при всей значимости показателя
урожайности, на современном этапе все более актуальной становится оценка
протекающих параллельно с ростом урожаев ряда важных процессов. Известно, что
даже в таких высокопродуктивных почвах, как черноземы в связи с экстенсивным
земледелием наметилась тенденция снижения почвенного плодородия: уменьшаются
запасы органического детрита, гумуса, разрушается почвенная структура,
устойчивость к эрозии. По данным В.А. Ковды, европейские черноземы потеряли
запасы гумуса примерно вдвое по сравнению с тем, что было 100 лет назад, во
времена В.В. Докучаева (Сельскохозяйственная экология, 1997). Исследованиями
научно-исследовательских институтов Сибирского Отделения РАСХН установлено, что
за 100-150 лет использования черноземные почвы утратили 10-20% гумуса в пахотном
слое (Адаптивно-ландшафтные системы…, 2002).
Для предотвращения деградационных
процессов в почвах страны в последние годы разработаны и внедряются
ландшафтно-зональные системы земледелия. В Новосибирской области для
большинства хозяйств рекомендована, как наиболее приемлема в ближайшее время,
ординарная система земледелия (Гамзиков, 2000). Она обладает сравнительно
невысокой затратностью и поддерживает устойчивый уровень продуктивности зерна
до 15 ц/га. Ординарная система земледелия предусматривает наряду со
строгим выполнением простейших агротехнических приемов применение
агрохимикатов. Это применение минеральных туков локально при посеве культур,
выборочное применение при острой необходимости химических средств борьбы с
сорняками, болезнями и вредителями и органические удобрения. Система применения
удобрений в хозяйстве составляется как стратегический план в расчете на
агроклиматические ресурсы, с учетом плодородия земель, уровня интенсификации,
структуры посевных площадей и планируемой урожайности культур.
Величина урожайности культур в нашей зоне
во многом зависит от обеспеченности растений усвояемым азотом. Он наиболее
часто выступает в виде фактора, лимитирующего урожайность, особенно в восточных
районах области, в том числе в Приобском агроландшафтном районе. Обеспеченность
этой территории осадками в сочетании с ее дренированностью формирует промытость
почвенного профиля. При распашке промывание профиля почвы усиливается. К тому
же эти земли распаханы уже минимум два века, и лабильные фракции органического
вещества, за счет которых в основном минерализуется азот, существенно истощены
(Адаптивно-ландшафтные системы…, 2002). Г.П. Гамзиковым (1981) показано, что в
сибирских черноземах минимум общего азота содержится в черноземах Приобья
(0,39%), а максимум - в черноземах Кузнецкой котловины (0,52%). В остальных
геоморфологических провинциях среднее содержание азота в выщелоченных
черноземах находится в пределах 0,43-0,44%. При оптимальных условиях увлажнения
(60% от полной влагоемкости) и температуре (24-26°С) в черноземах накапливается
около 35 мг/кг нитратного азота. В среднем же в сибирских черноземах
накапливается от 18 до 23 мг/кг нитратного азота (Гамзиков, 1981).
Получение устойчиво высоких урожаев
зерновых культур на черноземах Новосибирского Приобья требует оптимизации
азотного режима агроценозов. Даже сторонники биологического земледелия признают
необходимость минеральных удобрений для компенсации потерь питательных веществ
из пашни (Кант, 1988; Минеев, 1993). Их внесением достигается прямая компенсация,
что одновременно прямо или косвенно отражается на физических, химических и
биологических качествах почвы. Органические удобрения, наоборот,
непосредственно изменяют физические и биологические параметры почвы и вторично
служат источником элементов для растений.
Агрономической наукой установлено и
подтверждено практикой сельского хозяйства, что одним из основных приемов
рационального использования органических и минеральных удобрений является
совместное их применение. На этот прием, как наиболее эффективный, указывал
академик В. Р. Вильямс. Он первый выдвинул положение о том, что питать надо не
только растения, а необходимо кормить также бактериальное население почвы,
которое играет важную роль в питании высших растений (Мишустин, 1972).
Отмечая большое значение приема
совместного применения органических и минеральных удобрений, академик Д. Н.
Прянишников указывал, что при сочетании быстро- и сильнодействующих минеральных
удобрений с навозом и другими органическими удобрениями предоставляется
возможность установить правильное соотношение между элементами пищи растений в
зависимости от свойств почвы и требований сельскохозяйственных культур (Кант,
1988).
Высокие урожаи можно получить как по одним минеральным, так и
органическим удобрениям. Однако при правильном их сочетании устраняются
специфические недостатки обоих видов удобрений и тем самым создаются условия
наиболее рационального их использования (Ягодин, 1989, здесь и далее).
Необходимо иметь в виду, что значительная часть питательных
веществ органических удобрений становится доступной растениям лишь по мере их
минерализации. В связи с этим применением одних органических удобрений трудно
обеспечить потребность растений в элементах питания, в частности, в первый
период вегетации и в период максимального потребления ими питательных веществ.
В отличие от органических, многие минеральные удобрения
быстродействующие. Содержащиеся в них питательные вещества могут использоваться
растениями с момента внесения их в почву. При помощи минеральных удобрений
легче обеспечить меняющуюся потребность растений в питании в течение вегетации.
При использовании одних органических удобрений соотношение
питательных веществ в них может быть не таким, какое необходимо для нормального
роста и развития растений. Внесением минеральных удобрений или сочетанием их с
органическими можно создать любое требуемое растением соотношение питательных
элементов.
Однако использование только минеральных удобрений нередко
приводит к ухудшению некоторых свойств почвы. Так, при систематическом применении
физиологически кислых удобрений в дерново-подзолистых почвах увеличиваются
кислотность, содержание подвижного алюминия, усиливается химическое закрепление
фосфатов. В то же время при внесении органических удобрений повышается
буферность почвы, уменьшается подвижность железа и алюминия, фосфор
суперфосфата слабее закрепляется в почве. бесхлорный удобрение пшеница подкормка
При использовании только минеральных удобрений вероятность
образования вредной для растений концентрации почвенного раствора гораздо
больше, чем при сочетании минеральных и органических удобрений. Такая опасность
особенно велика на легких малобуферных почвах при внесении высоких доз
минеральных удобрений. Некоторые культуры, например, кукуруза, очень
чувствительны к повышенной концентрации почвенного раствора, особенно в первый
период вегетации. Для них совместное применение органических и минеральных
удобрений имеет явное преимущество перед внесением только минеральных.
Изучению эффективности различных
оптимальных сочетаний органических удобрений с минеральными в агрохимической
науке всегда уделялось большое внимание (Ковальчук, 1957; Чекалов, 1958;
Никитаева, 1972 и др.). Сотрудниками Центральной опытной станции ВИУА было
проведено сравнительное испытание эффективности различных видов органических
удобрений, включая подстилочный навоз, солому и зеленое удобрение. Варианты
органических удобрений выравнивали по сумме питательных элементов за счет
внесения минеральных удобрений. По трехлетним данным, действие навоза, соломы и
сидератов, применяемых в сочетании с минеральными удобрениями, было
равнозначным и более эффективным по сравнению с одними минеральными удобрениями
(Мерзлая и др.,1989).
На дерново-подзолистых почвах за 20-летний
период исследований ВИУА при эквивалентном внесении основных элементов питания
в зернопропашном севообороте стационарного полевого опыта установлено, что при
повышенном и высоком уровне применения удобрений (3 и 4 дозы NРК)
преимущественное положение по влиянию на продуктивность севооборота и гумусное
состояние почвы занимала органоминеральная система. Особенно влияло на
урожайность культур севооборота совместное применение азотных минеральных
удобрений и навоза. Наибольший эффект от удобрений был получен при внесении их
в умеренно средних дозах: по 45-90 кг азота под озимую рожь и по 30-60 кг азота
под яровые зерновые культуры на фоне последействия 20-40 т/га навоза
(Мерзлая и др.,1989).
Есть данные о высокой эффективности
применения органоминеральных удобрений даже в монокультуре. Так, на Терском
госсортоучастке, расположенном в засушливой степной зоне, А.М. Эльмесов и С.М.
Бесланеев (2002) показали, что кукуруза на удобренном фоне при бессменном
посеве на одном и том же месте не снижает, а в некоторых случаях повышает
урожай. Причем было замечено, что эффективность удобрений повышалась в
зависимости от продолжительности посева кукурузы без чередования с другими
культурами. Так, в первые 2 года прибавка урожая от ежегодного внесения 20 т/га
полупревшего навоза, 90 кг фосфора и 90 кг азота под вспашку составила 3,2
ц/га, в следующие 2 года - 8,5 ц/га. Самым лучшим вариантом оказалось внесение
органоминеральных удобрений дробно: под вспашку, в рядки при посеве и в
подкормку.
Следует отметить, что применение навоза
остается актуальным не только с точки зрения увеличения урожайности культур, но
и более полной утилизации отходов животноводства, что имеет природоохранное
значение.
При существенном удалении полей от ферм,
что удорожает доставку навоза, в зернотравяных или зернопаровых севооборотах
применение минеральных удобрений можно сочетать с использованием на удобрения
соломы или сидератов. При урожайности зерновых культур 20-30 ц/га с соломой в
почву может быть возвращено 10-15 кг азота, 5-8 кг фосфора, 20-35 кг калия. В
связи с широким соотношением С:N в соломе злаков, вместе с ней необходимо внести азотные
удобрения, доза которых рассчитывается с учетом содержания азота в соломе,
количества запахиваемой соломы и соотношения С:N в ней (Методическое
руководство…, 2005). В среднем на 1 т соломы необходимо вносить 10 кг азота.
Установлено, что при необходимости
внесения больших доз азота сочетание минеральных и органических удобрений
позволяет значительно уменьшить дозу минерального удобрения, способствует
лучшему и эффективному его использованию (Методическое руководство…, 2005).
Эффективность удобрений можно повысить, применяя медленнодействующие и
капсулированные сложные удобрения с контролируемой скоростью высвобождения
азота. Кроме того, повышение эффективности удобрений неразрывно связано с
ростом культуры земледелия, особенно со снижением засоренности посевов и
увеличением влаги в почве.
Применение органоминеральных удобрений -
важный фактор улучшения качества почвы, они способствуют поддержанию содержания
в ней органического вещества (Шевцова, 1988). Установлено, что длительное
применение таких удобрений в Сибири на 19-38% повышает содержание углерода
органического вещества почв против 10-18% при минеральной системе удобрений.
Это происходит за счет более высокого накопления биомассы микроорганизмов,
корневых и пожнивных растительных остатков, которые служат резервом для
гумификации и минерализации. При этом увеличивается доля гуминовых и наиболее
мобильных фракций гумусовых кислот. Возрастает содержание общего и
легкомобильных органических соединений азота, а также количество его
минеральных форм (Гамзиков, 2004).
Таким образом, применение
органоминеральных удобрений служит эффективным средством регулирования
продуктивности сельскохозяйственных культур, потенциального и эффективного
плодородия почв. При этом снижается риск негативного влияния удобрений на
окружающую среду.
1.2 Микроорганизмы почвы и действие на них
сложных удобрений
Почвенные микроорганизмы
- это обязательный компонент практически всех наземных экосистем. С их
деятельностью связано формирование почвы и протекание в ней важных процессов.
Почвенная микрофлора участвует в круговороте веществ и энергии, от её
жизнедеятельности зависит плодородие почвы, её биологическая активность, а
также способность к самоочищению. Сообщества микроорганизмов, являясь продуцентами
ферментов, осуществляют процессы трансформации органических веществ в почве.
По микробному
разнообразию почва - самая богатая среда обитания по сравнению с водой,
геологическими отложениями, силосом и другими средами. Почва не только лучшая
среда обитания для микроорганизмов, но и лучшая среда для их сохранения и
выживания (Звягинцев, 1987).
В микрофлоре почвы выделяют три большие группы организмов:
бактерии, грибы и актиномицеты.
Бактерии. В основном в
почве преобладают бактерии. По литературным данным (Звягинцев, 1978), их
количество в почвах составляет от 1 млн. до 1 млрд., а иногда несколько
десятков миллиардов клеток на 1 г почвы.
Бактерии, выделяемые на
обычных питательных средах, аммонифицируют в почве белки и пептоны. Как
источник азота они могут использовать также соли аммония, нитраты и
аминокислоты. Как источник углерода используют ряд углеводов, спирты и
органические кислоты (Мишустин, 1975).
Среди бактериального
населения почвы есть микроорганизмы, связывающие молекулярный азот. Подробно
изучена экология анаэробных азотфиксаторов Clostridium и аэробного Azotobacter. Из видов этой бактерии
в почве обычно встречается Az. chroococcum. Этот микроорганизм
требователен к условиям среды: развивается в достаточно увлажненных почвах,
имеющих реакцию, близкую к нейтральной, обеспеченных фосфором, калием и рядом
микроэлементов. Такая требовательность делает понятной причину его
ограниченного распространения в ряде почв. В зоне обыкновенных и южных
черноземов азотобактер обычно появляется как весенний эфемер.
В последнее время
выяснилось, что нет отдельных физиологических групп азотфиксаторов и
денитрификаторов. Одна и та же бактерия проводит оба процесса в зависимости от
условий окружающей среды. При наличии органического вещества и недостатке связанного
азота в среде происходит азотфиксация. Если же имеется органическое вещество
при избытке связанного азота и недостатке кислорода - идет денитрификация. Если
бактерия азотфиксатор-денитрификатор в процессе своего роста использует белки
или аминокислоты, она становится аммонификатором. Обычно бактерии могут
проводить и гетеротрофную нитрификацию. Таким образом, генетические возможности
микробов оказались очень обширными (Звягинцев, 1987).
Актиномицеты - одна из
многочисленных групп почвенного микронаселения, исчисляемая в миллионах /1 г. В
почве находится большое количество гиф актиномицетов. Они возбуждают процесс
аммонификации и могут разлагать разнообразные углеродсодержащие соединения.
Некоторые актиномицеты способны разрушать клетчатку, но перегнойные соединения
не разлагают (Мишустин, 1975).
Микроскопические грибы.
Численность их составляет несколько тысяч в 1 г почвы, но суммарная длина
грибных гиф на 1 г почвы равняется тысячам метров (Звягинцев, 1987). Грибы
способны разлагать белковые соединения и могут быть по этому признаку
причислены к аммонификаторам. Они разрушают многие углеродсодержащие вещества,
в том числе минерализуют циклические соединения и перегной. Некоторые из
несовершенных грибов, встречающихся в почве, являются фитопатогенами.
Отдельные слои пахотного
горизонта довольно существенно различаются по богатству микроорганизмов. При
благоприятных условиях влажности слой 0-5 см содержит в два раза больше
микробов, чем слой 20-30 см. При тождественном химическом составе в пределах
пахотного горизонта верхний слой отличается существенно большей энергией
микробиологических процессов. В основном это результат худшего проникновения в
глубокие слои почвы кислорода воздуха. В целине это различие сказывается более
резко.
Зарегистрирована неравномерность
в заселении почвенных горизонтов отдельными микроорганизмами, особенно родами Bacillus, Clostridium, Pseudomonas и Bacterium. В пахотной почве
споровые бактерии Bacillus чаще встречаются в поверхностном слое, в то
время как Clostridium и Bacterium - в нижних слоях. Что
касается грибов, они предпочитают верхние слои в связи с их большей
аэрируемостью.
Под влиянием
растительности почва не теряет характерных признаков специфики микробного
ценоза. Тип почвообразовательного процесса сказывается на микробном населении
сильнее всего (Мишустин, 1975).
К настоящему времени
накоплено много сведений о биологическом состоянии различных почв. На основании
этих данных, полученных в основном Е.Н. Мишустиным с сотрудниками, а в Сибири
Н.Н. Наплёковой, И.Л. Клевенской и другими сотрудниками НИИ Почвоведения и
Агрохимии СО РАН, были установлены следующие эколого-географические
закономерности распространения микроорганизмов:
) географический фактор,
оказывающий решающее влияние на почвообразовательный процесс, специфически
воздействует и на почвенные микроорганизмы;
) численность
микроорганизмов возрастает от северных почв к южным;
) в почвах различных
типов существенно изменяется соотношение отдельных групп микробонаселения,
) определенные типы почв
характеризуются наличием в них специфических видов микроорганизмов и их
группировок (Клевенская и др., 1970).
Агроиспользование почв существенно изменяет почвенные
биотические сообщества. Известно, что почвы агросистем отличаются от
естественных биогеоценозов меньшим видовым богатством микробов, но бόльшим обилием ряда видов и интенсивным протеканием
микробиологических процессов (Мишустин, 1972). При окультуривании почв разных
типов четко прослеживается усиление микробиологической и ферментативной
активности, увеличение интенсивности минерализации и трансформации почвенного
органического вещества (Минеев, 1990). При длительном экстенсивном земледелии
ухудшаются развитие органотрофной микрофлоры, азотфиксация и накапливаются
патогенные микробы (Артамонова, 2002).
Многочисленные опыты научно-исследовательских учреждений
убедительно показывают, что совместное внесение органических и минеральных
удобрений способствует энергичному развитию биологических процессов в почве.
После внесения таких удобрений при благоприятных климатических условиях
многократно возрастает численность микроорганизмов. Внесение смеси усиливает
размножение всех физиологических групп микроорганизмов, переводящих недоступные
для растений вещества почвы и удобрений в усвояемые элементы корневого питания.
Увеличивается выделение почвой СО2, что является следствием более
энергичного микробного разрушения органических остатков, возрастает
нитрификационная способность почвы (Мишустин, 1972). Внесение малых доз
органо-минеральных удобрений оказывает на микрофлору, развивающуюся под
растением, не меньшее стимулирующее действие, чем внесение больших доз навоза
для озимой пшеницы.
Особенного внимания заслуживают факты усиленного размножения
в ризосфере удобренных органо-минеральной смесью растений анаэробных фиксаторов
азота (Clostridium pasteurianum и олигонитрофилов).
Фосфорные и калийные соединения, входящие в состав сложных удобрений усиливают
активность свободноживущих и симбиотических азотфиксаторов. Даже через 3 года
после внесения гранул органо-минеральных смесей, состоящих из суперфосфата и
перегноя, в черноземе Прииртышья наблюдались очаги повышенного содержания
бактерий и подвижной фосфорной кислоты, как в самой грануле, так и в почве
вокруг нее (Сорокина, 1962).
Наиболее сильное влияние органо-минеральные смеси оказывают
на микрофлору прикорневого слоя почвы, который в биологическом отношении
является наиболее активным. Как отмечает Т.А. Сорокина (1962) удобренные
растения имеют корневую систему более мощно развитую, с большим количеством
корневых волосков. Благодаря этому микроорганизмы, развивающиеся в зоне
деятельности корней, испытывают двойное влияние: непосредственное удобрений и
косвенное растений, что и приводит к особенному усилению микробиологической
активности в прикорневом слое почвы. Здесь резко возрастает количество таких
важнейших для питания растений групп микроорганизмов, как нитрификаторы,
азотфиксаторы, бактерии, переводящие органические и трудно усвояемые
минеральные формы фосфора в доступную форму. Повышенное количество фосфора
наблюдается в течение длительного времени, обычно вплоть до цветения. Что
касается нитратов, то увеличение содержания их в прикорневом слое под влиянием
органо-минеральной смеси можно заметить лишь в начальный период развития
растений. Объясняется это тем, что мощно развивающиеся растения сильнее
поглощают нитраты, поэтому, несмотря па усиленную деятельность микроорганизмов,
нитраты под растениями обнаруживаются в меньшом количестве.
Итак, совместное внесение органических и
минеральных удобрений является мощным фактором влияния на почвенную микрофлору.
В механизме действия удобрений существенным моментом является то, что они
усиливают рост растения, а это в свою очередь вызывает стимуляцию
жизнедеятельности микрофлоры. С другой стороны, вызванная удобрениями
интенсификация микробиологических процессов приводит к мобилизации
питательных веществ самой почвы, благодаря чему также улучшается питание
растения. Таким образом, получается сложная цепь причинной зависимости,
основным звеном которой являются микроорганизмы почвы.
.3 Фитосанитарный эффект применения
органо-минеральных удобрений
Внося удобрения, мы не только улучшаем условия питания
растений, но и усиливаем их способность сопротивляться неблагоприятным
факторам, в том числе размножению нежелательной микрофлоры на корнях и
надземной массе. Кроме того, элементы, входящие в состав удобрений, могут прямо
ингибировать развитие грибных возбудителей болезни. Так, Л.К. Хацкевич (1987)
рекомендует применять в севооборотах с высоким насыщением зерновыми культурами
органо-минеральные удобрения, которые усиливают микробиологическую активность
почвы и подавляют споруляцию в ней возбудителей корневых гнилей. Интенсивная
споруляция патогенов приводит к формированию в почве такой высокой плотности
спор, что заболевание растений принимает эпифитотийный характер. Например, в
зерновых районах Канады на зараженных полях обнаруживалось в среднем около 200
конидий возбудителя гельминтоспориозной корневой гнили в 1 г почвы, что
вызывало хроническое заражение растений (Schreiber, 1963).
Проблема подавления популяций патогенов,
сохраняющихся и размножающихся в почве, с помощью агротехнических мероприятий
(и в частности, удобрений) не потеряла свою актуальность и в настоящее время.
Показано, что повышенная концентрация минеральных удобрений способствует
активизации возбудителей инфекции (Апаев и др., 1999). Там, где в
дерново-подзолистую почву вносились высокие дозы минеральных удобрений (N120P120K120) патогенные грибы,
вызывающие развитие корневой гнили, встречались так же часто, как в почве
контрольных участков. В вариантах, где вносили навоз (240 т/га - под
предшественник озимую рожь), отмечено повышенное содержание в почве сапрофитных
грибов, в частности микромицета Тrichoderma lignorum, являющегося активным
антагонистом патогенных грибов. При этом наблюдалось снижение пораженности
растений корневой гнилью на 34 %. Внесение минеральных удобрений по фону
органических повышало общую биологическую активность почвы, содержание в ней
антагонистов - грибов родов Fusarium, Drechslera, Rhizocthonia и снижало численность и
жизнеспособность популяций патогенных микромицетов под покровом яровой пшеницы
на 36,6-53,8%, по сравнению с контролем.
По данным многолетних исследований Г.П.
Мартынова (1999) в Республике Марий Эл фитосанитарное состояние почвы, которое
определяется общей численностью микромицетов и потенциальных патогенов
культурных растений, было наиболее благополучным в вариантах с внесением
торфонавозного компоста (ТНК) в разных сочетаниях с минеральными туками. Так,
при внесении в занятый пар 80-100 и 40-60 т/га ТНК и N48-71P71-95K64-99 показатель самозащиты
почвы составил перед уборкой ячменя соответственно 3,6 и 2,1, урожайность -
24,9 и 17,1 ц/га, заражение зерна альтернариозом - 5,6 % и 22,1 %, заселение
патогенными грибами, вызывающими корневые гнили, - 11 и 54,2 споры на 1 зерно.
На Украине при внесении полного
минерального и органического удобрения развитие корневых гнилей на озимой
пшенице снижалось с 46,7 до 18,5% (Чулкина, 1985).
Как правило, снижение потенциала
возбудителей в почве под влиянием органо-минеральных или органических удобрений
связано с активизацией почвенной микрофлоры. В Сибири в значительной степени
активизируют почвенную микрофлору органические удобрения (навоз и солома). При
этом повышается численность антагонистов-актиномицетов и антагонистов-бактерий
к возбудителям корневых гнилей в почве, что обусловливает снижение
инфекционного потенциала (Кузнецова, Коробова, 1982). В Канаде для усиления
микробиологических процессов в почве на сильно инфицированных полях
рекомендуется запахивать высокую стерню вместе с азотными удобрениями.
Разложение соломы ускоряется при внесении аммонийной формы азота, так как
именно эту, а не нитратную форму азота предпочитают усваивать почвенные
микроорганизмы (Чулкина, 1985).
Добавление к органическим удобрениям
минеральных позволяет достичь благоприятного соотношения между популяцией
патогенов и популяцией антагонистов, которое составляет примерно 1:8 (Чулкина,
1995). Такого мощного ингибирующего эффекта против B. sorokiniana, по мнению автора, не было
отмечено ни при каком другом агротехническом приеме борьбы с болезнью.
Например, зеленые удобрения, активизируя сапрофитную и антагонистическую
микрофлору, снижают численность возбудителя в почве, а предрасположенность
растений к возбудителю болезни при этом может возрастать. Поэтому лучшим
вариантом является совместное применение органических и минеральных удобрений.
В этом случае недобор зерна от болезни снижается в 5-6 раз по сравнению с
применением одного только органического удобрения (Чулкина, 1979).
Итак, применение органо-минеральных
удобрений может рассматриваться как интенсивный прием снижения инфекционного
потенциала возбудителей в почве. Он обеспечивает максимальное подавление
развития корневых гнилей из-за уменьшения предрасположенности растений к
возбудителю инфекции.
2.
Характеристика места и условий проведения исследований
Работа выполнялась в 2004
и 2005 годах на посевах яровой пшеницы на опытном поле Агрономического
института НГАУ в учебно-опытном хозяйстве «Тулинское» и на кафедре агроэкологии
и микробиологии.
Тулинский совхоз организован в 1932 году.
С 2000 года является федеральным государственным унитарным предприятием НГАУ.
Землепользование учхоза расположено в юго-западной части Новосибирского района
Новосибирской области. Центральная усадьба с. Тулинское находиться в 4 км от
областного центра г. Новосибирска. Расстояние до ближайшей железнодорожной
станции Клещиха - 12 км, до пристани г. Новосибирска - 25 км. Общая площадь
земель, закрепленных за учхозом 5368 га, площадь сельскохозяйственных угодий
4615 га, что составляет 86,4 %.
2.1
Природно-климатические условия зоны
Климат
Учхоз располагается на территории левобережной части
Новосибирского сельского района на северо-востоке Новосибирской области, на
Приобском плато. Это лесостепная зона Западной Сибири. Климат здесь
континентальный и характеризуется продолжительной холодной зимой и жарким
коротким летом с умеренным увлажнением. Весна обычно холодная с частым
возвратом поздних заморозков. Осень продолжительная, с умеренным увлажнением.
Средняя температура января -18º С, средняя температура
июля - +18-20°С.
Продолжительность теплого периода составляет 188 дней.
Средняя продолжительность безморозного периода - 120 дней, вегетационного
периода 160 дней. Безморозный период в районе начинается в 8 годах из 10 после
31 мая. Угроза заморозков исчезает во все годы после 14 июня. Сумма активных
температур составляет от 1800 °С до 1900 °С. Продолжительность активной
вегетации сельскохозяйственных растений заканчивается во второй декаде сентября.
Первый заморозок осенью наблюдается обычно
с 18 сентября. Среднемноголетняя дата установления устойчивого снежного покрова
- 1 ноября. Средняя продолжительность сохранения снежного покрова - 170 дней с
колебаниями по годам от 148 до 184 дней. Максимальная глубина промерзания почвы
- 257 см. В середине марта высота снежного покрова достигает 40-50 см. С 13
апреля устойчивый снежный покров нарушается. Полный сход снежного покрова
обычен к 21 апреля. Начало полевых работ, т.е. физическая спелость почвы, наступает
27 апреля.
Характерная особенность зоны -
преобладание ветров юго-западного направления, что особенно характерно для
зимнего периода. В летнее время ветры могут быть любых направлений, с
преобладанием юго-западного и южного направления.
Годовое количество осадков составляет 367 мм. Одна треть
осадков (82 мм) выпадает в виде снега, две трети - за теплый период года.
Максимум осадков приходится на июль - 79-75 мм.
Условия зоны исследований благоприятны для выращивания ранне-
и среднеспелых сортов яровой пшеницы и картофеля, всех сортов озимой ржи, овса,
ячменя, гречихи, гороха.
Растительность
Растительность в хозяйстве характерная для
лесостепной зоны. Леса занимают 5,4% территории и размещаются в основном по
оврагам и балкам, а также в виде колков в микропонижениях. Из древесной
растительности встречаются береза и осина. В травостое преобладают лабазник,
тысячелистник, кровохлебка. Из сорняков на территории хозяйства постоянны
вьюнок полевой, осот полевой, просо сорно-полевое. Большая часть территории -
74,7% распахана и занята посевами сельскохозяйственных культур.
Почвенный покров
Почвенный покров хозяйства сравнительно
однороден. Среди почв преобладают черноземы выщелоченные и оподзоленные,
которые с учетом комплексов этих почв с темно-серыми слабооподзоленными (их
доля в комплексах от 15 до 35%), занимают 99% пахотных земель. Черноземы
расположены на повышенных участках равнины, склонах равнины, склонах увалов и
используются под пашню. Темно-серые слабооподзоленные, серые оподзоленные и
светло-серые оподзоленные почвы размещаются на понижениях, склонах увалов,
днищах балок. Частично они используются под пашню, но основная их часть занята
лесом и кормовыми угодьями (Рекомендации, 1978).
2.2 Специализация
хозяйства и экономическая характеристика состояния производства
ФГПУ учебно-опытное хозяйство «Тулинское» является
многоотраслевым с преимущественным развитием производства молока, элитных семян
зерновых культур, племенного молодняка крупного рогатого скота и свиней. Здесь
находится кафедра НГАУ, где разрабатывают новые технологии возделывания
сельскохозяйственных культур и содержания животных.
В структуре товарного производства
продукция растениеводства по итогам 2004 года составила 34%, животноводства 65%
(в том числе реализация молока 44%, мяса крупного рогатого скота и свиней 49%),
прочие отрасли составили 1%.
Цех животноводства обеспечивает
выращивание племенного молодняка крупного рогатого скота и свиней, производства
мяса, молока, свинины. На 1 января 2004 года в учхозе было 1350 голов крупного
рогатого скота, в том числе 500 коров; 1020 голов свиней, в том числе основных
свиноматок 120 голов.
Цех растениеводства обеспечивает выращивание элитных семян
зерновых культур, вывозку минеральных и органических удобрений, выращивание и
доставку к животноводческим фермам кормов, вывоз продукции с полей до сдаточных
пунктов.
Посевная площадь в учебно-опытном хозяйстве составляет 4077
га пашни. Из общей площади посевов самый большой удельный вес занимают зерновые
культуры (табл. 2.1).
Таблица 2.1
Структура посевных площадей в хозяйстве и
урожайность за 2002-2004 гг.
|
Показатель
|
Единицы
измерения
|
2002
|
2003
|
2004
|
|
Структура
посевных площадей
|
|
зерновые
|
га
|
2150
|
2300
|
2300
|
|
картофель
|
га
|
78
|
50
|
50
|
|
кормовые -
всего в т.ч.
|
|
корнеплоды
|
га
|
20
|
20
|
20
|
|
многолетние
травы
|
га
|
878
|
980
|
980
|
|
однолетние
травы
|
га
|
454
|
320
|
615
|
|
Урожайность:
|
|
зерновые (амб.
вес)
|
ц/га
|
33,4
|
23,3
|
34,8
|
|
картофель
|
ц/га
|
290
|
312
|
345
|
|
многолетние
травы на сено
|
ц/га
|
34,7
|
38,5
|
27,3
|
|
Корм.
корнеплоды
|
ц/га
|
556
|
253
|
643
|
|
|
|
|
|
|
|
|
Уровень урожайности сельскохозяйственных культур в 2005 году
в хозяйстве составил: пшеница - 37,2 ц/га; ячмень - 40,8 ц/га; овес - 31,2
ц/га; картофель - 305,5 ц/га; сено многолетних трав - 37,5 ц/га; кукуруза - 705
ц/га.
2.3 Погодные условия лет
исследования
год по гидротермическим условиям был
умеренно-увлажненным. За период май-август количество осадков составило 215,6
мм при многолетней норме 223 мм. Однако первая половина вегетации яровой
пшеницы (до колошения) проходила в условиях острой воздушно - почвенной засухи.
Это обусловило значительную гибель растений на начальных этапах развития.
Середина вегетации (3 декада июня, 1 декада июля и первая декада августа),
напротив, сопровождалась обильными осадками, что позволило пшенице сформировать
хороший колос и максимально реализовать потенциал урожайности.
Метеорологические условия вегетационного периода 2004 г. приведены в таблице
2.2.
Таблица 2.2
Метеорологические показатели
вегетационного периода в Новосибирском районе в 2004 г. (данные
Новосибирской ГМС)
|
Месяц
|
Т°С
|
Осадки, мм.
|
|
Декады
|
Средне-месячная
|
Многолетняя
норма
|
Декады
|
В сумме за
месяц
|
Многолетняя
норма
|
|
1
|
2
|
3
|
|
|
1
|
2
|
3
|
|
|
|
Май
|
9,4
|
21,1
|
16,9
|
15,8
|
10,3
|
7
|
0,1
|
19
|
26,1
|
36
|
|
Июнь
|
17,7
|
20,6
|
18,7
|
19,0
|
16,7
|
0,6
|
5
|
25
|
30,6
|
58
|
|
Июль
|
16,1
|
19,9
|
18,8
|
18,3
|
19,0
|
83
|
10
|
10
|
103
|
72
|
|
Август
|
16,2
|
17,8
|
13,5
|
15,8
|
15,8
|
49
|
0
|
7
|
56
|
66
|
|
|
|
|
|
|
|
|
|
|
|
|
|
|
|
|
|
|
|
2005 год по
гидротермическим условиям относился к умеренно увлажненным и теплым годам. За
период май-август количество осадков составило 224 мм при многолетней норме 223
мм. Но в две первые декады мая дождей практически не было. Общее количество
майских осадков не превысило 72% от многолетней месячной нормы. Напротив, июнь
и июль сопровождались обильными осадками, на уровне 140% от среднемесячной
нормы, что способствовало проявлению
корневой гнили.
В августе, когда наливалось зерно яровой пшеницы,
установилась сухая погода (выпало 27% осадков от месячной нормы), что не
позволило пшенице полноценно реализовать потенциал ее урожайности.
Метеорологические условия вегетационного периода года приведены в таблице 2.3.
Таблица 2.3
Метеорологические показатели вегетационного
периода в Новосибирском сельском районе в 2005 году (данные Новосибирской ГМС)
|
Месяц
|
Т0С
|
Осадки, мм
|
|
Декады
|
Среднемесяч ная
|
Многолетняя
норма
|
декады
|
В сумме за
месяц
|
Многолет няя
норма
|
|
1
|
2
|
3
|
|
|
1
|
2
|
3
|
|
|
|
Май
|
8,6
|
14,3
|
12,6
|
11,9
|
10,3
|
0
|
1,0
|
25,0
|
26,0
|
36
|
|
Июнь
|
15,7
|
19,6
|
19,7
|
18,3
|
16,7
|
30,0
|
17,0
|
34,0
|
81,0
|
58
|
|
Июль
|
23
|
17,9
|
19,9
|
20,3
|
19,0
|
17,0
|
37,0
|
45,0
|
99,0
|
72
|
|
Август
|
21,5
|
16,6
|
16,0
|
18,0
|
15,8
|
4,0
|
5,0
|
9,0
|
18,0
|
66
|
|
|
|
|
|
|
|
|
|
|
|
|
|
|
|
|
|
3. Объекты и методы
исследования
.1 Объекты исследований
Объектами исследования в опытах были
яровая пшеница сортов Сибирская 12 и Новосибирская 29, гельминтоспориозная
корневая гниль яровой пшеницы, чернозем выщелоченный и населяющие его
микроорганизмы.
1. Яровая пшеница Яровая мягкая пшеница (Triticum
aestivum L.) относится к семейству Мятликовых (Poaceae).
Народнохозяйственное
значение пшеницы. Среди зерновых культур особое место принадлежит пшенице. Ее
посевами занято около 50% площадей зерновых в стране. Пшеница - это не только
хлеб и мучные изделия, но и продукты животноводства, так как значительное
количество зерна используется на кормовые цели, а также продукты экспорта и
переработки на технические цели, это, наконец, семенное зерно.
Наряду с увеличением общего объема производства зерна большое
народнохозяйственное значение имеет улучшение его качества. Ценность пшеницы
определяется ее химическим составом, технологическими и пищевыми достоинствам.
Эти свойства связаны с особенностями сорта и условиями выращивания. Внедрение в
производство новых, наиболее продуктивных и ценных по качеству сортов пшениц -
важное условие повышения эффективности сельского хозяйства.
Ботаническая
характеристика. Корневая система мочковатая, состоит из двух типов корней:
первичные или зародышевые и вторичные или узловые. Корневая система у пшеницы
развита слабо и составляет 40-45% от общей массы растения. Она проникает в
почву на глубину до 1 м и более. Но основная масса корней (до 80%) расположена
в слое почвы 0-40 см.
Стебель - соломина, высотой от 50 до 120
см, имеет 4-6 узлов и 5-7 междоузлий. К каждому узлу соломины прикрепляется
листовое влагалище, которое охватывает междоузлия в виде трубки и переходит в
листовую пластинку. Листовая пластинка линейная с параллельными рядами жилок. В
месте перехода листового влагалища в листовую пластинку находиться язычок и
ушки. Язычок препятствует попаданию воды между листом и стеблем.
Соцветие - колос. Колос состоит из
стержня. Стержень из члеников, к каждому из которых прикрепляется колосок. С
боковой стороны колоса имеется два ряда колосков, с лицевой стороны колоски
расположены черепицеобразно.
Плод зерновка.
Особенности развития. Элементы структуры
урожая пшеницы формируются по мере прохождения растениями фенофаз и этапов
органогенеза. Семена пшеницы начинают прорастать при температуре верхнего слоя
почвы 3-4 °С, когда содержание воды в семенах достигнет 45-52%. При высоком
качестве семян, соблюдении нормы сева, способа, глубины и срока посева всходы
полные и дружные. Дружность всходов имеет решающее значение для формирования первого
элемента структуры урожая - количества продуктивных стеблей на единице площади
(Растениеводство,1979).
С появлением 3-4-го листа
начинает формироваться второй элемент структуры урожая - число зёрен в колосе.
Идёт формирование зачаточного соцветия - колоса, наступает кущение. В этот
период определяется судьба урожая. Одновременно с формированием количества
зерен в колосе происходит развитие вторичной корневой системы: нижний ярус
составляют зародышевые и эпикотильные корни (первичные), верхний - узловые корни,
развивающиеся из узла кущения (вторичные). Чтобы вырастить хороший урожаи,
необходимо хорошее развитие и первичных, и вторичных корней (Иванов, 1954;
Куперман, 1956). Развитие вторичной корневой системы тесно связано с кущением.
Яровая пшеница хуже кустится, чем другие зерновые культуры (Растениеводство,
1979).
У большинства сортов яровой пшеницы
формируется 7-8, а у поздних сортов 9 листьев. Числу стеблевых листьев
соответствует число междоузлий. До фазы кущения и несколько позже все
междоузлия остаются укороченными, интенсивный рост их начинается только перед
фазой выхода в трубку и продолжается вплоть до цветения. Рост последней
листовой пластинки заканчивается примерно за неделю до колошения.
Колос закладывается во время кущения при
появлении третьего листа. Формирование и рост всех органов цветка заканчивается
в фазу колошения, а в фазу цветения происходит опыление и
оплодотворение. Сильное снижение урожайности бывает при засухе в период от
выхода в трубку до колошения. Она влияет на число зёрен в колосе
(Растениеводство, 1979).
Формирование третьего
элемента структуры урожая, массы 1000 зёрен, происходит в фазы начала налива -
полной спелости зерна. Период от оплодотворения до начала молочной спелости
сопровождается быстрым увеличением сырой массы, размеров семени и развитием
зародыша. Полное развитие зародыша заканчивается к концу молочной спелости. В
период молочной спелости, когда зерновка заполняется запасными питательными
веществами, следствием засухи является щуплое зерно (Растениеводство, 1979).
В начале восковой
спелости влажность зерна снижается до 35-38%. При такой влажности связь с
материнским растением нарушается, и дальнейшее поступление пластических веществ
прекращается. Показатель влажности зерна может служить объективным критерием для
начала уборки яровой пшеницы.
Требования культуры к температуре. Для нормального роста и
развития всходов пшеницы и дальнейшего её развития очень важен правильный выбор
срока посева. В Сибири возврат холодов весной иногда повреждает всходы пшеницы,
и сильно задерживает их развитие. Также возможны и ранние осенние заморозки,
которые захватывают пшеницу в незрелом состоянии, вызывая повреждение зерна.
Для борьбы с осенними заморозками в Сибири рекомендовано вводить скороспелые и
морозостойкие сорта (Новосибирскую 22, Лютесценс 57 и др.) (Интенсивная…,
1986).
Прорастание семян яровой пшеницы возможно при температуре 1-2
° С, а появление жизнеспособных всходов - при 4-5 °С. Наиболее устойчива к
низким температурам яровая пшеница в самые ранние фазы. В период прорастания
зерна она переносит заморозки до -13° С, в фазе кущения - до - 8-9°С, но во
время цветения повреждается заморозками в 1-2° С. Кущение лучше проходит при
температуре 10-12°С (Растениеводство, 1979).
Влияют на урожай и высокие температуры. При достаточном
количестве влаги в почве температура 30 °С переносится пшеницей в фазы
колошения-налива зерна без снижения урожая, а температура 35°С снижает урожай
на 11-22%. При 40 °С урожай падает на 43-48%. Дальнейшее повышение температуры
воздуха вызывает катастрофическое падение урожая на 71-83% (Куперман, 1956).
Требования яровой пшеницы к свету. Свет, или лучистая
энергия, является важнейшим энергетическим фактором, участвующим в создании
органического вещества, его превращениях и запасе. Он влияет косвенно и
непосредственно на процессы закаливания растений, изменение их зимостойкости и
засухоустойчивости. К тому же изменения в интенсивности света зачастую тесно
связаны с изменением и температурного режима растений. Действуя одновременно,
они ведут к существенным изменениям в прохождение ряда микробиологических
процессов в почве, и, следовательно, ухудшают не только фотосинтез, но и
почвенное питание растений (Куперман, 1956).
Так как пшеница возделывается в очень широких географических
ареалах, то разные сорта её приспособились к разной длине дня, характерной для
каждого района. Сорта пшеницы северного происхождения более требовательны к
длинному дню продолжительностью не менее 14-16 часов. Чем длиннее день, тем
быстрее пшеница выколашивается и зацветает. Сорта пшеницы южного происхождения
могут проходить световую стадию при 12-14 часовой длине дня (Куперман, 1956).
Для избежания затенения пшеницы необходимы борьба с сорняками
и соблюдение оптимальной для зоны нормы высева.
Требования культуры к влаге. Изучение закономерностей водного
режима яровой пшеницы имеет особенно большое значение, так как основные посевы
её размещаются в засушливых районах России. В Западной Сибири засуха наиболее
часто повторяется весной.
Потребление влаги растениями подвержено большим колебаниям в
зависимости от условий года и фазы развития. Однако общая закономерность
потребления влаги определяется биологией культуры.
Пшеница извлекает влагу в основном из метрового слоя почвы,
причём до колошения использует, главным образом, запасы влаги в слое до 60-70
см, а в последующем - с глубины 90-100 см (Иванов, 1954).
Для прорастания семян мягкой пшеницы требуется 50-60% воды от
массы сухого зерна. Периоды кущения и выхода в трубку - критические для яровой
пшеницы. При недостатке влаги в почве в этот период увеличивается количество
бесплодных колосьев. Наиболее благоприятна для растений влажность почвы в
пределах 70-75% от наименьшей влагоёмкости.
Требования к почвам. Яровая пшеница весьма требовательна к
наличию в почве легко доступных питательных веществ, что объясняется её
сравнительно коротким периодом вегетации и пониженной усвояющей способностью
корневой системы. Пшеница страдает от повышенной почвенной кислотности. Для неё
благоприятны нейтральные и слабо кислые почвы (рН б,0-7,5) (Растениеводство,
1979). Из почв Западной Сибири самыми лучшими для пшеницы являются черноземы.
Менее благоприятны для нее темно-каштановые почвы. Однако при высокой
агротехнике и на этих почвах можно получить большой урожай пшеницы.
Система предпосевной
обработки почвы, посева и ухода за посевами
Комплекс мероприятий весенней подготовки
почвы к посеву должен быть направлен на сохранение влаги, выравнивание
поверхности, улучшение структуры верхнего слоя почвы и уничтожение сорняков.
Ранневесеннее боронование проводят при достижении физической спелости почвы.
Отвальные фоны лучше бороновать зубовыми боронами БЗТ - 1,0, БЗСС - 1,0 поперек
вспашки или по диагонали в 2-4 следа до равномерного разрыхления верхнего 3-4
см слоя почвы. На стерневом фоне эту работу выполняют ротационными игольчатыми
боронами. В засушливых условиях поле прикатывают кольчатыми катками.
При появлении сорняков отвальные фоны
обрабатывают культиватором КПС - 4 или лущильником на глубину 4 - 5 см,
стерневые - культиватором КПЭ -2,1. После культивации обязательно боронование,
а в засушливых условиях - прикатывание. Можно одновременно уничтожать сорняки и
вносить удобрения сеялкой СЗС -2,1. Фосфорные удобрения вносят на глубину 10-12
см, если они не были внесены осенью при основной обработке. В засушливое лето
при низких запасах влаги удобрение вносят при посеве в рядки в небольших дозах.
Предпосевную обработку проводят
культиватором КПС - 4 по отвальному фону и КПЭ - 3,8 или СЗС - 2,1 по
плоскорезному фону на глубину 5-6 см с последующим боронованием и при
необходимости прикатыванием. Невыровненные поля после культивации планируют, а
затем боронуют.
В каждой зоне определены свои оптимальные
сроки посева пшеницы: в степной зоне и южной лесостепи - это 18-25 мая, в
северной лесостепи и подтайге - это 22-23 мая.
Один из основных факторов получения
высокого урожая зерна - оптимальная густота стеблестоя, которая зависит от
нормы высева. Для подтаежной зоны оптимальные нормы высева пшеницы составляют
6,0-7,5 млн. семян на га, северной лесостепи 4,5-6,0, южной лесостепи 3,5-4,5,
для степной зоны 3,0-3,5 млн. всхожих семян на га.
Полевая всхожесть сильно зависит от
глубины заделки семян. Оптимальная глубина для северной лесостепи и подтайги на
легких почвах 4-6 см, на тяжелых 3-4 см, в степной зоне соответственно 5-7 см и
4-5 см.
Посевы, засоренные однолетними сорняками,
необходимо бороновать до и после всходов. Послепосевное боронование проводят
тогда, когда размер проростков еще не превышает длину семян. Послевсходовое
боронование проводят легкими боронами на необходимой скорости (4 км/ч) при
оптимальной густоте растений пшеницы в начале кущения и при достаточной
влажности верхнего слоя почвы.
Особенности минерального
питания яровой пшеницы
Яровая пшеница требовательна к
минеральному питанию. Интенсивность потребления биогенных элементов в различные
периоды развития неодинакова. Пшеница наиболее чувствительна к условиям питания
при закладке точек роста. Больше всего минеральных элементов растение
потребляет в период между кущением и молочной спелостью, во время максимального
наращивания вегетативной массы, поэтому содержание их в почве должно быть
высоким с самого начала вегетации. Особенно это касается фосфора, в котором
яровая пшеница в первые дни вегетации более всего нуждается: он способствует
усиленному росту корневой системы. Очень высокие прибавки урожаев от рядкового
внесения удобрений связаны как раз с интенсивным узловых корней, которые
успевают использовать уходящую влагу. Фосфорное голодание в раннем возрасте не
может быть компенсировано позднее.
Для формирования крупного колоса с большим
числом колосков и зерен необходим, прежде всего, азот. В то же время фосфор
ускоряет дифференциацию зачаточного колоса. Недостаток питательных веществ в
период цветения и оплодотворения яровой пшеницы может вызвать отмирание
цветков. Дефицит азота в это время приводит к стерильности пыльцы, а недостаток
фосфора - к уменьшению числа цветков. И то и другое снижает озерненность
колоса. В калии пшеница нуждается в основном до фазы цветения. Максимальная
потребность в нем приходиться на период стеблевания - начало налива зерна.
Накопление минеральных элементов
заканчивается в период налива, и сам налив в большей мере идет за счет
перераспределения элементов, их передвижения из вегетативных органов в зерно. В
засушливое лето это происходит уже к началу налива, в благоприятное по
увлажнению - до молочной спелости. Поэтому азотные подкормки в фазу
колошения-цветения положительно влияют на содержание белка в зерне, а иногда на
урожайность.
Для нормального протекания обменных процессов
необходимо поддерживать в растениях оптимальную концентрацию микроэлементов.
Снижение ее на 25% приводит к отрицательным последствиям дефицита
микроэлементов.
Пшеница при урожае зерна 20 ц выносит с га
почвы 200 - 250 мг марганца, 50 - 70 цинка, 50 - 60 бора, 20 - 25 меди, по 4 -
5 мг молибдена и кобальта. При таком урожае микроэлементов для удовлетворения
потребностей растений, как правило, оказывается достаточно. При планировании
более высоких урожаев следует учитывать обеспеченность микроэлементами.
Характеристика используемых сортов. В наших опытах
использовались районированные в зоне сорта: Новосибирская 29 и Сибирская 12.
Новосибирская 29 - сорт создан методом
межсортовой географически отдаленной гибридизации ППГ - 38/1 «Б» (Мексика) х
Новосибирская 22 (Западная Сибирь) и индивидуального отбора. Авторы сорта: П.Л.
Гончаров, Н.В. Вивенков, В.В. Советов. Это разновидность Лютесценс. Форма куста
прямостоячая. Стебель выше средней толщины, прочный полный. Лист имеет слабое
опушение в период кущения, по ширине промежуточный. Цвет листа светло-зеленый.
Колос близок к пирамидальному, белый, средней длины и плотности. Зерно крупное,
удлиненной формы, красной окраски, с глубокой, хорошо выраженной бороздкой.
Сорт среднеранний. Вегетационный период 70-78 дней. Позднеспелее Новосибирской
22 на 3 дня.
Растения сорта на инфекционном фоне слабо поражаются пыльной
головней, мучнистой росой, средне - бурой ржавчиной, т.е. значительно слабее,
чем Новосибирская 22. Сорт обладает исключительно высокой устойчивостью к полеганию,
устойчив к прорастанию на корню.
По содержанию белка Новосибирская 29 (16,9%) стабильно
превосходит стандарт (15,2%). Содержание клейковины в зерне выше, чем у
стандарта Новосибирской 22 (31%). Качество клейковины в отдельные годы в
большей мере соответствует ценной пшенице (свыше 80% единиц ИДК). Сила муки
(476 е.а.) выше стандарта на 133 е.а. Масса 1000 зерен 35,4 г.
Объем хлеба выше, чем у стандарта на 67 м3. Общая
хлебопекарная оценка хорошая - 4,2 балла, но слабее, чем у Новосибирской 22, на
0,3 балла. Сорт формирует зерно на уровне сильной пшеницы. Дает высокую
урожайность по паровому предшественнику, однолетним травам, отзывчивым на
высокие дозы внесения минеральных удобрений и способен формировать урожай свыше
50 центнеров с гектара.
Сорт Сибирская 12. Сорт мягкой яровой пшеницы
Сибирская 12 создан лабораторией генетики Сибирского НИИ растениеводства
и селекции СО РАСХН совместно с кафедрой селекции и генетики Новосибирского
государственного аграрного университета методом сложной ступенчатой
гибридизации (1971-2002 гг.). Авторы: Р.А. Цильке, А.А. Тимофеев, П.Л.
Гончаров, Л.П. Тимофеев, Е.Р. Ребенкова.
В конкурсном сортоиспытании 2000-2002 гг.
по паровому предшественнику средняя урожайность зерна составила 50,2 ц/га, что
на 10 ц больше, чем у стандарта.Новый сорт устойчив к засухе, полеганию и
прорастанию зерна на корню. Хлебопекарные качества муки хорошие. Содержание
клейковины 25-32 %, белка 14-15 %. Масса 1000 зёрен 35 - 38 г.
Сорт относится к среднеспелой группе.
Агротехника обычная. Для предотвращения засорения семян сорт рекомендуется
размещать по пару. Норма высева всхожих семян на 1м2 - 550-600.
Глубина заделки семян - 3-4 см. Перед посевом и после посева почву обязательно
прикатать кольчатыми катками.
2. Почва Почвенный
покров опытного участка представлен черноземом выщелоченным среднегумусным,
среднемощным, тяжелосуглинистым.
Образование черноземов выщелоченных приурочено к зоне
уравновешенного или несколько избыточного увлажнения. Эти почвы в настоящее
время полностью распаханы. Профиль черноземов выщелоченных и гумусовый горизонт
хорошо развиты, карбонаты относительно глубоко выщелочены (80 - 130 см), однако
дифференциация на элювиально-иллювиальные горизонты выражена слабо. Им
свойственен сравнительно мощный гумусовый горизонт в 40-60 см (который
позволяет проводить глубокую основную обработку), благоприятные водные,
воздушные и физико-химические свойства. Все это позволяет возделывать
практически все районированные сельскохозяйственные культуры и получать высокие
и устойчивые урожаи.
Строение профиля представлено горизонтами Апах+АВ+В+ВС+Ск
. В зависимости от степени выщелоченности черноземы подразделяются на
слабо- и средне выщелоченные. С увеличением выщелоченности усиливается
иллювиированность профиля, которая морфологически выражается в большой
уплотненности горизонта В и, в отдельных случаях, наличием кремнеземистой
присыпки на границе перехода горизонта АВ в горизонт В.
Таблица. Описание чернозема выщелоченного среднемощного
среднесуглинистого
|
Аn
|
0-24 см:
|
темно-серый, однородно окрашенный, рыхлый комковато-пылеватый,
суглинистый, встречаются корни растений, переход заметен по сложению;
|
|
А1
|
темно-серый, уплотненный, комковато-зернистый, встречаются корни
растений, переход заметен по плотности;
|
|
В1
|
36-55 см:
|
грязно-желтый, есть потеки гумуса, плотный, ореховато-зернистый,
суглинистый, единичные корни растений, кротовины, заполненные почвой из верхних горизонтов,
переход заметен по цвету
|
|
В2
|
55-92 см
|
пылеватый,
однородно окрашенный, зернисто -
ореховый, суглинистый, кротовины, переход резкий по цвету и вскипанию;
|
|
Ск
|
92 и глубже:
|
палевый, однородно окрашенный, плотный, зернисто-ореховатый, влажный,
суглинистый, карбонаты в виде мучнистой присыпки и белоглазки; бурно вскипает с
глубины 92 см.
|
Черноземы выщелоченные характеризуются высокой влагоемкостью
и способны удерживать до 44% влаги от массы почвы. В слое 100 см может
накопиться до 300 мм влаги, что составляет 80 - 90% годового количества
осадков. При этом впитывание влаги в черноземах происходит довольно быстро.
Пахотный горизонт черноземов, как правило, имеет излишнюю
рыхлость, что может привести к быстрой потере влаги. Чтобы избежать этого, вся
агрономическая деятельность должна быть направлена на сбережение почвенной
влаги (Семендяева, 2001).
По содержанию
гумуса (5,67 - 6,4% в слое 0-40 см) почва опытного участка
относится к среднеобеспеченным. С глубиной содержание гумуса довольно плавно
снижается Обеспеченность подвижными формами фосфатов и обменного калия 15,0 и
16,0 мг/100 г почвы, легкогидролизуемым
азотом - 7,7 мг/100 г почвы. Реакция среды
близка к нейтральной, рН 6,6.
3. Обыкновенная корневая гниль и её возбудители
Обыкновенная корневая
гниль относится к числу малозаметных внешне, но весьма вредоносных и опасных
заболеваний пшеницы в зонах производства товарного зерна (степь, лесостепь).
Распространена повсеместно. Основной возбудитель - несовершенный гриб Bipolaris sorokiniana (Sacc.) Shoemaker,
синоним Helminthosporium sativum (Дубынина,1980).
Гриб
развивается при температуре от 0 до 40°С (оптимум 22-26°С). Грибница
коричневая, располагается по межклетникам тканей злаковых культур. На
поверхности поражений образуется конидиальное спороношение,
выходящее через устьица или между клетками эпидермиса.
Конидиеносцы многоклеточные, тёмные, коленчатые. Конидии темно оливковые,
веретеновидные или удлинёно-яйцевидные, прямые или изогнутые (Чулкина,
1985). Образуются в основном в июле-августе на отмирающей надземной части
растений, осыпаются в почву и сохраняются там до 8-10 лет.
В Сибири более 60% пахотных почв заселено B. sorokiniana, вследствие чего яровая
пшеница на огромных массивах ежегодно возделывается на инфекционном фоне.
Ситуация усугубляется характерным для Сибири дефицитом влаги в ранневесенний и
летний периоды.
Формы проявления гельминтоспориозной
корневой гнили - корневая гниль, бурая пятнистость листьев и черный зародыш
зерна.
Признаки корневой гнили - светло-бурые или
темно-коричневые некротические пятна, полоски, охватывающие частично или
полностью подземные (первичные, вторичные корни, эпикотиль) или надземные
(колеоптиле, прикорневые листья, стебель) органы растений.
Бурая пятнистость проявляется
преимущественно на стеблевых листьях в виде овальных темно - бурых пятен разной
величины.
Черный зародыш зерна. В области зародыша
или на всей поверхности зерновки появляются сначала светло - коричневые, а
затем темно-коричневые пятна. Эти разные формы одной и той же болезни, которые
обусловлены способностью возбудителя, передаваться через почву, в том числе
через инфицированные растительные остатки, семена и воздушными течениями.
Способ передачи возбудителя и форма болезни зависят от почвенно-климатических,
погодных и агротехнических условий.
Кроме гельминтоспориозной гнили корневую
систему злаков повреждают фузариозы. В степных районах Сибири распространена
преимущественно гельминтоспориозная, в подтаежных - фузариозная, а в
лесостепных гельминтоспориозно - фузариозная корневые гнили. В технологиях
выращивания эпифитотиология корневых гнилей меняется. На удобренном фоне
возрастает физиологическая устойчивость растений к инфекции и способность почв
подавлять паразитическую активность патогенов. Несмотря на это, борьба с
корневыми гнилями в условиях интенсификации земледелия необходима, так как при
заболевании выше допустимого порога нет отдачи от минеральных удобрений, на
вегетирующих растениях приходиться применять больше фунгицидов, повышается
восприимчивость растений к засухе. Отрицательное действие корневых гнилей
больше проявляется при внесении высоких норм азотно-фосфорных удобрений
(Чулкина, 1985).
В Сибири большое значение имеет снижение
вредоносности гельминтоспориозной корневой гнили, возбудитель которой первым
заражает растение, «открывая дорогу» возбудителям фузариозной корневой гнили, а
также провоцируя развитие целого ряда гнилей неинфекционной породы. Для
разработки мер борьбы с заболеванием следует предварительно определить
фитосанитарное состояние почвы. Определять фитосанитарное состояние полей,
выделенных под выращивание культуры, следует по группам предшественников.
Периодичность определения - раз в 3-5 лет. Как правило, почву отбирают осенью,
а анализ делают зимой.
Меры борьбы с корневыми гнилями должны
быть направлены на оздоровление почв и предупреждение передачи возбудителей
через семена и воздушными течениями. Повысить физиологическую устойчивость и
выносливость растений к инфекции можно такими мероприятиями, как оптимальная
глубина посева семян и посев протравленными семенами.
3.2 Методы исследований
Методы микробиологических исследований. В почвах
изучали численность бактерий, усваивающих
органический, минеральный азот и
азотфиксаторов (участвующих в круговороте азота), целлюлозолитических микроорганизмов (участвующих в круговороте
углерода), а также численность
актиномицетов, микромицетов (грибов) и олигонитрофильных
микроорганизмов. Образцы для микробиологических исследований отбирали до
посева, через 7 дней после посева протравленных семян и в июле, через 60 дней
после посева, что совпало с месячным ожиданием после химпрополки. Образцы
отбирали в 20 точках с варианта из слоя почвы 0-20 см.
Для
выделения микроорганизмов использовали метод высева на плотные
питательные среды. Определенный объем исследуемой суспензии высевали
на плотную среду в чашки Петри и в последующем считали число выросших
колоний.
Численность
бактерий, усваивающих органический азот, учитывали на
мясопептонном агаре (МПА); бактерий, усваивающих минеральный азот
и актиномицетов - на крахмало-аммиачном агаре (КАА); грибов - на агаре Чапека (ЧА).
Численность олигонитрофилов - на голодном агаре (ГА); целлюлозолитических микроорганизмов - на агаре Гетчинсона.
Численность
свободноживущих азотфиксаторов, в частности Azotobacter,
учитывали на агаре Эшби по обрастанию комочков почвы. На поверхность
агара в чашку Петри помещали на равных расстояниях друг от
друга по 50 комочков почвы. Чашки Петри инкубировали в термостате при 28°С. Через 1-2 суток вокруг частиц почвы появлялись слизистые прозрачные
колонии Azotobacter,
постепенно приобретающие коричневую окраску.
Частоту встречаемости азотобактера учитывали на седьмые сутки. При этом число комочков почвы, в которых были
обнаружены эти бактерии, соотносили с
общим количеством комочков на чашке. Рассчитывали
процентную частоту встречаемости азотобактера по четырем-пяти повторениям.
Остальные
микроорганизмы высевали методом предельных разведений. Для этого
приготовляли навеску почвы 10 г, которую вносили в колбу, содержащую
90 мл стерильной водопроводной воды. Затем готовили почвенную
суспензию 3-го разведения - для глубинного посева грибов и 5-го разведения
- для поверхностного посева остальных групп микроорганизмов.
Чашки Петри инкубировали при температуре 28°С 3-7 дней. Число выросших
колоний, с учетом содержания почвенной влаги, объема
капли и разведения, пересчитывали на численность микроорганизмов в 1 г абсолютно сухой почвы. Минерализационный
коэффициент рассчитывали как соотношение бактерий на КАА к МПА.
Состав сред:
1) Агар
Эшби для культивирования аэробных азотфиксирующихбактерий: маннит -
20 г; К2НРО4 - 0,2 г; MgSO4х7H2O -
0,2г; NaCl - 0,2 г;K2SO4 -
0,1 г; СаСОз - 5 г; FеС13 -0,01 г;
агар - 20 г; дистиллированная вода -1000 мл.
2) Агар
Чапека: сахароза 30 г; NaNO3 2
г; К2НРО4 1 г;MgSO4х7H2O
0,5 г; КС1 -0,5 г; FeSO4-7H2O
0,01 г; агар 20 г; дистиллированная вода - 1000 мл.
3) Крахмало-аммиачная
питательная среда: растворимый крахмал -10 г; (NH4)2SO4 1
г; MgSO4х7H2O 1
г; NaCl 1г; СаСО3 3 г; дистиллированная
вода - 1000 мл; агар - 20 г.
4) Голодный агар:
агар - 20 г; дистиллированная вода - 1000 мл.
5) Мясопептонный агар: мясной бульон; водопроводная вода;пептон -1 %; поваренная соль - 0,5 %; 0,1 Н
раствор NaOH; агар - 20 г.
6) Агар Гетчинсона: СаСl2- 0,1 г; К2НРО4 -
1 г; MgSO4х7H2O -
0,3 г;NaCl -0,1 г; NaNO3 - 2,5 г, FеС13- 0,01 г; агар - 20 г; дистиллированная
вода- 1000 мл, диск фильтровальной бумаги (Сэги, 1983).
Метод определения
биологической активности почвы
Биологическую активность почвы учитывали
по инициированной уреазной активности по экспресс - методу Т.В. Аристовской
(Аристовская, 1989). Согласно этой методике отбирали 200 г почвы, делали 5%
раствор мочевины. На 200 г почвы выливали 10 мл маточного раствора,
перемешивали и раскладывали каждый вариант по трем чашка Петри (три
повторности) по 50 г почвы. Чашки с лакмусовой индикаторной бумагой помещали во
влажную камеру и регистрировали значения рН через 45 мин., через 1,5 час., 20,
21, 45 и 68 час..
Методы
фитопатологических исследований
Метод микологического
анализа. Зараженность семян патогенными грибами определяли до и
после протравливания. Из партий протравленных и непротравленных
семян отбирали по 5 кг зерна, из которых составляли средний
образец массой 1 кг. Из него методом квадрата выделяли 2 несмежные
повторности. Семена, обеззараженные КMnО4
от внешней инфекции, закладывали на питательный агар Чапека в чашки
Петри, по 100 штук из каждой повторности. Культуры грибов, выросших на семенах,
инкубировали 7 дней, после чего проводили их определение.
Метод учета численности возбудителя обыкновенной корневой
гнили в почве.
Численность конидий патогена определяли методом флотации.
Перед анализом почву просеивали через сито диаметром 0,5 мм. Анализировали 10 г
почвы в двухкратной повторности. Образец помещали в центрифужный стакан объемом
100 мл и увлажняли 2 мм дистилированной воды. Почву растирали до пастообразного
состояния и добавляли 5 мл вазелинового масла и еще 48 мл воды.
Для лучшего извлечения конидий гриба суспензию встряхивали в
течение 5 минут, после чего выдерживали одни сутки. По истечении этого срока
наблюдали четкое расслоение: почва оседала на дно, а масляная суспензия с
конидиями возбудителя собиралась в верхнем слое.
Пипеткой с измеренным диаметром каплю суспензии переносили на
предметное стекло и подсчитывали количество конидий под микроскопом.
Повторность капель - шестикратная.
Для пересчета заселенности конидиями 1 г воздушно-сухой почвы
использовали формулу:
Х= У·5 / Vк ·10,
где
Х - число конидий гриба в 1г почвы; Vк - объем 1
капли;
- 5 мл вазелинового масла; 10 - 10 г почвы;
У - число конидий в 1 капле (Чулкина, 1979).
Метод учета пораженности растений обыкновенной корневой
гнилью
Степень
заболевания корневой системы растений определяли визуально по шкале, предложенной В.А.
Чулкиной (1979), дифференцированно по органам:
пораженность первичных корней, вторичных корней, эпикотиля, влагалища прикорневых листьев и основания стебля.
При площади поражения от 1 до 10%
присваивали балл 0,1, при площади 10 до 25% балл 1, 25-50% - балл 2; 50-75% - балл 3. Полностью пораженное растение соответствовало 4.
Развитие
болезни пересчитывали по формуле:
Рб,
% = Б• 100 / 4•А,
где
Рб,
- развитие болезни в %,
Б -
сумма балов по органу или растению,
А -
число органов или растений в учете,
4
-высший балл учетной шкалы.
Срок учета - фаза
развития пшеницы «полное кущение».
Учет биологического
урожая
Учет урожая проводили отбором снопов с площадок по 0,5 кв. м
в 8 повторениях в каждом варианте опытов в фазу полной спелости зерна. В снопе
анализировали количество растений, стеблей, колосьев, массу зерна. Также
учитывали число зерен в колосе и массу 1000 зерен.
Результаты
всех исследований математически обработали, используя компьютерную
программу «Snedecor» (автор О. Сорокин).
Методика закладки
опытов
В 2004 г. опыт закладывали как
производственный (рис. 3.1). Размер делянок 2 га., повторность однократная.
Почва участка - чернозем выщелоченный среднемощный,
среднесуглинистый с нейтральной реакцией среды. Культура: среднепоздний сорт
яровой пшеницы Сибирская 12. Сорт создан для лесостепной зоны Западной Сибири и
рассчитан на выпадение осадков во второй половине вегетации.
Агротехника: пшеница высевалась по предшественнику пшеница по
пшенице; в качестве основной обработки почвы применялась зяблевая
вспашка на глубину 22 см, боронование весной, предпосевная культивация и
прикатывание после посева.
Срок посева пшеницы - 13 мая. Норма высева семян пшеницы -
5,0 млн. семян на га, глубина заделки семян: 3-4 см.
Варианты опыта: 1. Контроль, без удобрений, 2. ОМУ
«Пшеничное», 50 кг/га, 3. Акварин-5, 1,5 кг/га. (Во всех 3 вариантах фоном
обрабатывали посев баковой смесью гербицидов Террамет 0,005 г/га +Октапон 0,3
л/га). 4. Эталон. В качестве эталона брали вариант общепринятой в зоне
технологии: протравливание семян препаратом Агат-25 К, ТПС, в дозе 40 мл/т
семян и обработка просева против двудольных сорняков гербицидом Кросс в дозе 60
мл/га.
ОМУ вносили перед посевом вручную с последующей заделкой в
почву культиватором. Гербициды и акварин вносили в фазу кущения (8.06) с
помощью тракторного опрыскивателя ОПШ-15 с нормой расхода рабочего раствора 200
л/га.
В 2005 г. опыт закладывался как производственный, в 2
повторениях. Размер делянки 1.2 га. Культура: среднеранний сорт яровой пшеницы
Новосибирская 29. Почва: чернозем выщелоченный среднемощный, среднегумусный,
тяжелосуглинистый с нейтральной реакцией среды.
Агротехника: пшеница высевалась по предшественнику картофель.
В качестве основной обработки почвы применялась зяблевая вспашка на глубину
22 см, боронование весной, предпосевная культивация и прикатывание после
посева.
Срок посева пшеницы - 14 мая. Норма высева семян - 5,0 млн.
семян пшеницы на га. Глубина заделки семян: 3-4 см.
Варианты опыта: 1. Контроль, без применения агрохимикатов; 2.
Комплексное гранулированное бесхлорное удобрение ОМУ «Пшеничное» - 50 кг/га; 3.
ОМУ + баковая смесь гербицидов октапона (0,3 л/га) с металтом (5 г/га); 4.
Удобрение для внекорневой подкормки «Акварин 5» - 1,5 кг/га + баковая смесь
гербицидов октапона (0,3 л/га) с металтом (5 г/га); 5. Баковая смесь гербицидов
октапона (0,3 л/га) с металтом (5 г/га).
Гербициды на посевы яровой пшеницы вносились в фазу кущения
(10.06). Препараты вносили с помощью тракторного опрыскивателя ОПШ-15 с нормой
расхода рабочего раствора 200 л/га.

Рис. 3.1 Вид посева яровой пшеницы сорта Сибирская 12 в
производственном опыте с удобрениями в 2004 г. (делянка с ОМУ «Пшеничное»)
4.
Результаты исследований
4.1 Влияние комплексных удобрений на урожайность
яровой пшеницы
Урожайность яровой пшеницы в оба года исследования на фоне
удобрений была существенно выше контроля (табл. 4.1). Внесение ОМУ больше
влияло на озерненность колоса, а подкормка Акварином 5 на выполненность зерна.
В итоге урожайность зерна увеличилась на 66-92%. В сравнении с эталоном в
условиях 2004 г. прирост урожайности составил 17-23%.
Зерно, полученное в опыте, было передано на анализ в СибНИИРС
СО РАСХН. Результаты показали, что в зерне яровой пшеницы в опытных вариантах
увеличилось содержание клейковины: на фоне ОМУ на 9% относительно контроля, на
фоне Акварина 5 - на 16%.
Таблица 4.1. Влияние удобрений на биологический урожай яровой
пшеницы
|
Вариант
|
Продуктивная
кустистость
|
Число зерен в
колосе, шт.
|
Масса 1000
зерен, г
|
Урожайность,
ц/га
|
|
2004 г.
|
|
Контроль
|
1,05
|
16,5
|
32,6
|
15,1
|
|
ОМУ «Пшеничное»
|
1,06
|
20,7
|
37,4
|
26,0
|
|
Акварин 5
|
1,13
|
23,1
|
39,2
|
27,8
|
|
Агат 25 К
(эталон)
|
1,11
|
16,3
|
35,2
|
21,4
|
|
НСР05
|
0,02
|
3,9
|
3,4
|
6,6
|
|
2005 г.
|
|
Контроль
|
1,03
|
17,6
|
34,8
|
14,8
|
|
ОМУ без
гербицидов
|
1,10
|
19,6
|
34,5
|
24,7
|
|
ОМУ с
гербицидами
|
1,27
|
18,2
|
37,8
|
24,9
|
|
Акварин 5
|
1,01
|
19,9
|
39,1
|
28,5
|
|
НСР05
|
0,22
|
1,3
|
2,8
|
5,2
|
4.2 Влияние комплексных удобрений на микрофлору
почвы
Внесение удобрений сопровождалось изменением биологической
активности пахотного горизонта почвы. Это один из важных показателей
агрономического состояния и эффективного плодородия почвы.
Изменения биологической активности зарегистрировали уже через
неделю после внесения удобрений. Общую реакцию микроорганизмов на внесение
удобрений определили по инициированной уреазной активности почвы в соответствии
с методикой Т.В. Аристовской. На рисунке значения рН соответствуют активности
почвенных микроорганизмов, разлагающих мочевину. Наиболее энергично мочевина
разлагалась в почве с внесенным ОМУ. В почве с Агатом 25К, привнесенным с
семенами, скорость процесса была несколько ниже, а в контрольном варианте
процесс шел очень медленно. При этом отставание в разложении мочевины в
неудобренной почве составило более 20 часов.

Рис. 4.1. Биологическая активность выщелоченного чернозема
через шесть дней после внесения удобрений и посева пшеницы
Поскольку между активностью уреазы и микробным индексом
плодородия почвы, а также средним урожаем растений установлена положительная
корреляция (Kucharski, 1996), можно считать, что уже через неделю после внесения удобрений
растения на фоне ОМУ имели лучшие, чем в контрольном варианте, условия для
роста и развития. Это подтверждают возросшая на 18% в 2004 г. всхожесть пшеницы
и в 2005 г. воздушно-сухая биомасса (на 42% в кущение) и длина растений (на
15%).
Если конкретизировать влияние удобрений на микробное
сообщество, то после внесения ОМУ в почве возросла численность всех основных
физиологических групп микроорганизмов (табл. 4.2). В первый год исследования
число бактерий-аммонификаторов увеличилось в 3,1 раза, бактерий, усваивающих
минеральный азот, по годам в 2 и 2,2 раза, актиномицетов в 6,8 и 2,5 раза,
микроскопических грибов в 2-2,2 раза .
Таблица 4.2.
Численность микрофлоры в чернозёме выщелочном
через 7 дней после внесения удобрений, млн. в 1 г абс. сух. почвы, 2004 г.
|
Группа
микроорганизмов
|
Вариант
|
|
Контроль
|
ОМУ
|
ОМУ+ Агат
|
НСР05
|
|
1.Бактерии,
усваивающие органический азот, МПА
|
20,6
|
64,0
|
15,8
|
9,9**
|
|
2.Бактерии,
усваивающие минеральный азот, КАА
|
62,3
|
136,8
|
197,1
|
41,6**
|
|
3.
Актиномицеты, КАА
|
0,4
|
2,7
|
0,8
|
|
|
4.Олигонитрофильные
микроорганизмы, голодный агар.
|
90,7
|
163,2
|
81,2
|
115,8
|
|
5. Грибы, агар
Чапека, тыс.
|
3,2
|
7,0
|
3,1
|
1,3**
|
|
Общая
численность микроорганизмов (Σ 1, 3 и 5 строк)
|
24,2
|
73,7
|
19.7
|
|
** различия достоверны для 0,05 % уровня значимости
В дальнейшем на состояние микрофлоры почвы, кроме удобрений,
оказывало влияние также физиологическое состояние растений. На такую
зависимость между почвенными условиями, развивающейся растительностью и
микроорганизмами почвы обратил внимание еще Вильямс. На шестидесятый день после
посева (который совпал с месячным ожиданием после химпрополки и внесения
Акварина) различия по вариантам сохранились (табл. 4.3).
Таблица 4.3.
Влияние
удобрений на ризосферную микрофлору через 60 дней после посева яровой пшеницы
(среднее за 2 года)
|
Группы микроорганизмов
|
Количество колониеобразующих единиц, КОЕ, млн. /1 г
|
НСР05
|
Степень влияния, %
|
|
Контроль
|
ОМУ
|
Акварин
|
|
|
|
Бактерии, усваивающие органический азот, МПА
|
215,0
|
266,6
|
255,4
|
40,6
|
63,0
|
|
Бактерии, усваивающие минеральный азот, КАА
|
22,3
|
55,2
|
60,3
|
38,8
|
45,3
|
|
Актиномицеты, КАА
|
1,1
|
0,8
|
1,2
|
0,6
|
27,2
|
|
Грибы, ЧА, тыс.
|
10,1
|
18,5
|
17,5
|
8,1
|
68,9
|
|
Олигонитрофильные, голодный агар
|
28,6
|
43,5
|
103,9
|
22,2
|
80,9
|
|
Целлюлозоразрушающие, агар Гетчинсона
|
12,4
|
10,8
|
13,9
|
15,7
|
0
|
|
Аэробные азотфиксаторы, Эшби, % обрастания комочков
|
36,0
|
58,7
|
64,0
|
19,5
|
59,6
|
|
Анаэробные азотфиксаторы, Эшби, % обрастания комочков
|
54,6
|
64,0
|
53,3
|
17,7
|
0
|
** различия достоверны для 0,05 % уровня значимости
В условиях 2004 г. они выявлены для бактерий-аммонификаторов
и грибов, а в 2005 г., кроме этого, для бактерий, усваивающих минеральный азот
и микрофлоры рассеяния, т.е. олигонитрофиллов, которые питаются остаточными
количествами азота. На фоне удобрений увеличивалась численность аэробных
азотфиксаторов. В варианте с ОМУ и Акварином активнее шла минерализация
органического вещества.
Таким образом, органоминеральное удобрение «Пшеничное» и
подкормка Акварином 5 создали в почве благоприятные условия для активизации
микробиологических процессов, что дало дополнительные резервы для питания
растений и в конечном итоге положительно сказалось на урожае.
4.3 Фитосанитарный эффект от применения
комплексных удобрений
В оба года в посеве яровой пшеницы сложилась неблагоприятная
фитосанитарная ситуация по корневой гнили (табл. 4.4). Болезнью было поражено
больше 70% растений, чему способствовал инфекционный фон возбудителя Bipolaris
sorokiniana в 70-72 конидий на г почвы и зараженность в 2004 году посевного
материала патогенными грибами.
Таблица 4.4
Влияние удобрений на развитие обыкновенной
корневой гнили яровой пшеницы (фаза начала выхода в трубку)
|
Вариант
|
Развитие
болезни, %
|
Распространенность
болезни, %
|
|
Корни
|
Эпикотиль
|
В среднем по растению*
|
|
|
первичные
|
вторичные
|
|
|
|
|
2004 г.
|
|
Контроль
|
11,4
|
10,0
|
7,7
|
8,4
|
74
|
|
ОМУ
|
2,1
|
1,8
|
2,3
|
1,9
|
9
|
|
ОМУ + Агат 25К
|
3,0
|
2,5
|
1,7
|
1,8
|
9
|
|
Агат 25К
(эталон)
|
9,5
|
4,6
|
5,1
|
5,2
|
54
|
|
НСР05
|
1,5
|
2,7
|
3,0
|
1,0
|
16,6
|
|
Степень
влияния, %
|
95
|
84
|
63
|
96
|
90
|
|
2005 г.
|
|
Контроль
|
12,9
|
16,5
|
15,1
|
12,0
|
86
|
|
ОМУ
|
12,4
|
9,1
|
7,8
|
8,2
|
59
|
|
НСР05
|
5,1
|
5,7
|
5,0
|
1,9
|
13,8
|
|
Степень
влияния, %
|
0
|
70
|
75
|
85
|
85
|
* с учетом влагалищ прикорневых листьев
Семена пшеницы на 12,5% были заражены B. sorokiniana
(порог 10%), на 7,5% грибами р. Fusarium (порог 5%) и на 80%
условно патогенными грибами р. Alternaria. Именно, исходя из
исходной зараженности семян, решили за базовый вариант технологии возделывания
пшеницы (эталон) взять вариант с протравливанием семян биологическим препаратом
агатом 25К, содержащим Pseudomonas aureofaciens. С ним сравнивали
фитосанитарный эффект от действия удобрений. Оценку пораженности растений
провели по органам на ранних стадиях развития растений, когда происходит
закладка будущего урожая.
Поражаемость растений корневой гнилью на фоне удобрений
снизилась. В среднем болезнь развивалась в 4,7 раз слабее, чем в контроле, и в
2,9 раз слабее по сравнению с базовым вариантом, агатом 25К. Этот
препарат неудовлетворительно защищал растения от «грибной черни», о чем
свидетельствует заболеваемость первичных корней и эпикотиля. Но в том случае,
когда протравленные им семена высевались по ОМУ, развитие и распространенность
болезни уменьшались. По-видимому, оздоравливающий эффект ОМУ в немалой степени
связан с увеличением поверхности корневой системы и поэтому относительно
меньшей площадью поражения растения.
В условиях следующего года, когда количество осадков в конце
мая и в июне составило 140% от нормы, фитосанитарное состояние пшеницы на фоне
ОМУ улучшилось для двух органов: вторичных корней и рецептора корневых инфекций
- эпикотиля.
Других заболеваний на яровой пшенице в условиях 2004 г. не
было. В 2005 г. в посеве развился септориоз (возбудитель Septoria tritici). При этом пораженность
листовой поверхности флагового листа в период налива зерна (23.07) достигала
30%. Видимых различий по заболеваемости растений септориозом в удобренном и
неудобренном посеве не выявлено.
Следующим этапом работы стал микологический анализ корневой
системы пшеницы. Он позволил выявить, в какой степени внешнее проявление болезни
соответствует наличию инфекции внутри корней. Оказалось, что зараженность
корней пшеницы возбудителями, в отличие от развития болезни, по вариантам была
примерно одинаковой (табл. 4.5). То есть, у растений, развивающихся в почве с
ОМУ, несмотря на наличие инфекции, болезнь не проявилась в силу возросшей
иммунности растений.
Таблица 4.5
Инфицированность корневой
системы яровой пшеницы возбудителями болезней на фоне ОМУ (фаза - конец
кущения)
|
Вариант
|
Корни
|
Эпикотиль
|
Влагалища
прикорневых листьев
|
В среднем по
растению
|
|
Bipolaris
sorokiniana
|
|
Контроль
|
3,8
|
22,5
|
10,0
|
10,0
|
|
ОМУ
|
3,8
|
20,2
|
2,5
|
7,5
|
|
Грибы рода Fusarium
|
|
Контроль
|
7,5
|
7,5
|
5,0
|
6,3
|
|
ОМУ
|
10,0
|
7,5
|
8,8
|
Таким образом, на фоне органоминерального
удобрения «Пшеничное» и подкормки Акварином 5 уменьшилась предрасположенность
растений яровой пшеницы к возбудителям корневых инфекций, что сопровождалось
выраженным фитосанитарным эффектом.
4.4 Фитосанитарное состояние почвы на фоне
сложных удобрений в последействии
Фитосанитарное состояние почвы определили по численности
основного почвенного патогена для зерновых культур в зоне, возбудителя
обыкновенной корневой гнили гриба B. sorokiniana. Он заселяет выше порога
вредоносности около 75% площадей пашни Западной Сибири. Плотность его популяции
в пахотных почвах довольно высока, что связано с насыщением севооборотов
зерновыми культурами. Порог вредоносности для этого патогена в выщелоченном
черноземе определен в 20 конидий/1 г возд.-сух. почвы (Чулкина, 1985).
Исходная численность патогена в пашне контрольного варианта в
июне 2006 г., на следующий год после применения удобрений, оказалась высокой,
257 конидий / 1 г почвы. В последействии органоминеральных удобрений количество
конидий возбудителя корневой гнили в почве оказалось меньше в 1,6 раза.
Подкормка Акварином 5 в последействии снизила плотность популяции Bipolaris sorokiniana по сравнению с контролем
в 1,8 раза (рис. 4.2).

Рис. 4.2. Последействие ОМУ «Пшеничное» и внекорневой
подкормки Акварином 5 на накопление в почве возбудителя корневой гнили, гриба Bipolaris sorokiniana (середина июня следующего
года)
Таким образом, после применения сложных удобрений запас
почвенной инфекции под следующую вегетацию несколько снизился, что позволяет
говорить о пролонгированном фитосанитарном эффекте изученных удобрений.
5. Экономическое обоснование
.1 Составление и расчет
технологической карты
Технологическая карта - плановый документ,
специальная таблица, приложение к производственно-финансовому плану
сельскохозяйственного предприятия (Организация производства…, 2002 и далее).
Методика составления и расчета
технологической карты:
. В бланк технологической карты вносятся
исходные данные, плановая площадь посева, урожайность, количество удобрений и
т.д.
. На основании типовой технологии и
технологии контрольного варианта составляется технология возделывания культуры,
т. е. перечень операций (работ) с учетом технологических требований.
. В бланк технологической карты вносится
нормативно-справочный материал (Справочник нормативов…, 1998): состав агрегата;
сменная эталонная выработка трактора, агротехнические сроки проведения работ;
обслуживающий персонал 1 агрегата; нормы выработки за смену; расход горючего на
1га, кг; тарифные разряды работников; ставки за норму.
. Рассчитываются производственные
показатели:
а) объем работ в физических единицах (в
гектарах, тоннах, штуках и т.д. в зависимости от вида работ)
б) количество нормосмен в объеме работ.
Определяется делением объема работ (в физических единицах) на норму выработки
да смену.
в) объем работ, выраженный в условных
эталонных гектарах (у.э.га). Определяется только для механизированных работ,
выполняемых тракторными агрегатами, умножением количества нормосмен в объеме
работ на сменную эталонную выработку трактора.
г) производительность агрегата: за 1 час
сменного времени (норма выработки за смену делится на продолжительность смены -
7 часов); за рабочий день (производительность агрегата за 1 час сменного
времени умножается на продолжительность рабочего дня); продолжительность рабочего
периода в рабочих днях. Определяется умножением продолжительности
агротехнического срока выраженного в календарных днях на поправочный
коэффициент (при агросроке до 10 дней - 0,9; от 10 до 15 - 0,85; >15 - 0,8),
который учитывает погодные условия, степень готовности техники и т.д.
е) выработка 1 агрегата за рабочий период.
Определяется умножением производительности агрегата за рабочий день на
продолжительность рабочего периода.
ж) потребность в технике на
запланированный объем работ: потребность в тракторах, самоходных комбайнах
определяется делением физического объема работ на выработку 1 агрегата за
рабочий период; потребность в сельскохозяйственных машинах определяется
умножением количества тракторов на количество сельскохозяйственных машин в 1 агрегате.
. Планируются затраты труда, материальных
и денежных средств на производство продукции:
а) затраты труда измеряются в
человеко-днях и определяются для каждой операции умножением количества
нормосмен на численность персонала, обслуживающего 1 агрегат.
б) затраты материальных средств - это
количество семян, удобрение, средств защиты растений, горюче-смазочных
материалов (ГСМ).
Количество основного горючего определяется
умножением норматива расхода на 1га на плановую площадь.
в) затраты денежных средств в
технологической карте планируются по следующим статьям: на оплату труда с
отчислениями; амортизацию основных средств; поддержание техники в
работоспособном состоянии; стоимость работ и услуг вспомогательных производств.
Планирование затрат на
оплату труда
При расчете затрат на оплату труда
используется тарифная система:
. Каждой технологической операции по
тарифно-квалификационному справочнику присваивается тарифный разряд.
. По 6 - разрядной тарифной сетке,
соответственно тарифному разряду, определяют тарифные ставки (ставки за норму).
Основой для начисления является тарифный
фонд (оплата по тарифу), который определяется умножением тарифной ставки на
количество нормосмен в объеме работ.
В основной фонд заработной платы входят,
кроме оплаты по тарифу, доплата за продукцию (50 %) от тарифа. Это
соответствует выполнению плана по урожайности на 100%.
Кроме основного фонда в общем затраты на
оплату труда входят все виды надбавок, доплат и отчислений.
При планирование рассчитывается
усредненный процент надбавки за классность (13%).
Надбавка планируется всем категориям
работников. Размер надбавки зависит от непрерывного стажа работы. При
планировании рассчитывается усредненный процент (16,1%).
Размер надбавки по зональному коэффициенту в Новосибирской
области - 25 %.
В технологической карте при определении
затрат на оплату труда рассчитывают сумму отчислений в отпускной (10,2%) и
внебюджетные фонды (29,6%).
Общая сумма затрат на оплату труда
определяется сложением всех начислений.
Методика планирования
затрат на горюче-смазочные материалы
Стоимость ГСМ определяется исходя из
количества ГСМ и комплексной цены 1ц сложного горючего (основное топливо,
смазочные масла, пусковой бензин).
Комплексная цена определяется для каждой
марки трактора или комбайна и включает в себя стоимость составных частей
горючего и доставку его от места приобретения (Организация производства…,
2002).
Исходные данные для определения
комплексной цены 1ц ГСМ (Типовые нормы…,2000): примерные нормы соотношений
составных частей ГСМ для различных марок тракторов и комбайнов; отпускные цены
на ГСМ; расстояние до нефтебазы (приемлемые условия); себестоимость 1
тонно-километра (12руб.).
Комплексная цена 1ц сложного горючего для
трактора К-700, Т-150 составила 1828,6 руб., для ДТ-75 - 1879,1 руб., Т-4 - 1899,5
руб., МТЗ-80 -1894,1 руб., СК-5 «Нива» - 166,5 руб..
После определения комплексной цены для
каждой технологической операции, где используется горючее, его стоимость
рассчитывается умножением цены на плановое количество горючего в центнерах.
Методика планирования
амортизационных отчислений
Амортизационные отчисления в
технологической карте рассчитываются по тем операциям, которые выполняются при
помощи основных средств производства (Организация производства…, 2002).
Методика расчета амортизационных отчислений
зависит от вида основных средств на каждой конкретной операции.
Амортизационные отчисления основных
средств по операциям, где используются тракторные агрегаты, определяются по
формуле
Ао = (Ртр + Рс.х.маш.)Vусл
Где Ртр - размер амортизационных отчислений
в руб. в расчете на 1 у.э.га. плановой наработки на данной марки трактора
Рс.х.маш. - размер амортизационных
отчислений в расчете на 1 у.э.га плановой наработки для данной группы
с.-х.машин.
Vусл - объем работ,
у.э.га.
Амортизационные отчисления основных
средств по операциям, где используется самоходная техника, определяются по
формуле
Aо = Р • Vфиз,
Где Р - размер амортизационных отчислений
в руб. в расчете на единицу плановой наработки для данного вида основных
средств;
Vфиз - объем работ, выраженный
в физических единицах.
Показатель Р - это не норматив, эта величина, которая
складывается в условиях каждого конкретного предприятия.
После расчета размера амортизационных
отчислений на единицу работы определяется сумма амортизационных отчислений по каждой
технологической операции по вышеприведенным формулам.
Методика планирования
затрат на поддержание техники в работоспособном состоянии
Затраты на поддержание техники включают
затраты на капитальные ремонты, текущие ремонты, технический уход и техническое
обслуживание средств производства (Организация производства…, 2002 и далее).
При расчете технологической карты эту
группу затрат рассчитывают аналогично и по тем же формулам, что и
амортизационные отчисления. В этих формулах вместо хозяйственного показателя Р
используют единые установленные нормативы отчислений в расчете на единицу
работ.
Затраты на поддержание техники в
работоспособном состояние по операциям, где работают тракторные агрегаты,
определяются по формуле:
Зп = (Нтр + Нс.х.маш.) Vусл.
где Нтр - норматив отчислений в рублях в
расчете на 1 у.э.га для данной марки трактора.
Нс.х.маш. - единый норматив отчислений в
руб. в расчете на 1 у.э.га для всех групп с.х. машин.
Vусл. - объем
работ(у.э.га)
Затраты на поддержание техники в
работоспособном состоянии по операциям, где работают самоходная техника,
определяются по формуле:
Зп = Н • Уфиз
Где Н - норматив отчислений в рублях в
расчете на единицу работы для данной группы средств производства.
5.2 Планирование затрат
на производство яровой пшеницы
Под себестоимостью понимается совокупность
материальных и трудовых затрат предприятия в денежной форме на производство
единицы продукции данного вида. Себестоимость продукции - это выраженная в
денежной форме та часть ее стоимости, которая возмещает затраты предприятия на
потребленные средства производства и оплату труда работников (Организация
производства…, 1985).
По способу распределения затрат в
производстве подразделяют на прямые и косвенные.
Прямые затраты - те денежные средства
которые включаются непосредственно в производство данного вида продукции к ним
относятся технологические затраты (оплата труда, стоимость ГСМ, амортизация,
стоимость ремонта, техническое обслуживание), стоимость работ и услуг
вспомогательных производств, стоимость семян, удобрений, средств защиты
растений, затраты полных лет и прочие (специальная одежда, инвентарь,
пусконаладочные производства).
Косвенные затраты - те денежные средства
которые включаются в общехозяйственные и общепроизводственные нужды. К ним
относятся заработная плата, ремонт и амортизация административных зданий,
стоимость ГСМ служебных автомобилей. Косвенные затраты включаются в
себестоимость каждого вида продукции по % которые складываются в условиях
каждого предприятия.
Затраты на стоимость органо-минеральных
удобрений и внекорневой подкормки «Акварин 5» показаны в таблице 5.1.
Полная себестоимость затрат складывается
из прямых и косвенных затрат.
Для расчета полной себестоимости
составляется справка по затратам (таблица 5.2 и 5.3).
Таблица 5.1.
Стоимость удобрений
|
Наименование
удобрения
|
Объем работ, га
|
Норма внесения,
кг/га
|
Всего, т
|
Цена 1т
|
Стоимость, руб.
|
|
ОМУ
|
100
|
50
|
5
|
3740
|
18700
|
|
«Акварин 5»
|
100
|
1,5
|
0,15
|
48000
|
7200
|
Таблица 5.2.
Справка по затратам при
применении органо-минеральных удобрений, руб.
|
Статьи затрат
|
Затраты по
традиционной технологии
|
Дополнительные
затраты
|
Затраты по
улучшению технологии
|
|
1
|
2
|
3
|
4
|
|
1 . Затраты
прошлых лет
|
78000
|
-
|
78000
|
|
2. Оплата труда
с отчислениями
|
11426,2
|
2806,1
|
14232,3
|
|
3. Стоимость
семян
|
120000
|
-
|
120000
|
|
4. Стоимость
органо-минеральных удобрений
|
-
|
18700
|
18700
|
|
5. Стоимость
гербицидов
|
-
|
12700
|
12700
|
|
5. Стоимость
ГСМ
|
48590
|
8334
|
56924
|
|
6.
Амортизационные отчисления
|
39609
|
1188,2
|
40797,2
|
|
7. Стоимость
ремонта и ТО средств производства
|
20666
|
780,4
|
21446,4
|
|
8. Стоимость работ
и услуг вспомогательных производств
|
10262,6
|
2100
|
12362,6
|
|
9. Прочие
прямые затраты
|
10755,18
|
716,2
|
11471,38
|
|
1
|
2
|
3
|
4
|
|
10. Затраты на
организацию и управление производством
|
21510,36
|
1432,4
|
22942,76
|
|
11. Затраты на
уборку дополнительной продукции
|
-
|
22563
|
22563
|
|
12. Итого
затрат
|
360819,3
|
71320,3
|
432139,6
|
|
13. Затраты
труда на весь объем работ, чел/дн.
|
35,1
|
9,4
|
44,5
|
Полная себестоимость продукции по опыту по
сравнению с контролем увеличивается. Затраты увеличиваются по статьям: оплата
труда на 2806,1 руб., стоимость ГСМ на 8334., амортизация на 1188,2 руб.,
ремонт и ТО на 780,4 руб., стоимость услуг на 2100 руб..
В общей сумме затрат по опыту
дополнительные затраты составляют 16,5%.
Таблица 5.3.
Справка по затратам, при
применении подкормки «Акварина 5», руб.
|
Статьи затрат
|
Затраты по
традиционной технологии
|
Дополнительные
затраты
|
Затраты по
улучшению технологии
|
|
1
|
2
|
3
|
4
|
|
1 . Затраты
прошлых лет
|
78000
|
-
|
78000
|
|
2. Оплата труда
с отчислениями
|
11426,2
|
1406
|
12832,2
|
|
3. Стоимость
семян
|
120000
|
-
|
120000
|
|
4. Стоимость
подкормки «Акварин 5»
|
-
|
7200
|
7200
|
|
5. Стоимость
гербицидов
|
-
|
12700
|
12700
|
|
6. Стоимость
ГСМ
|
48590
|
4167
|
52757
|
|
7.
Амортизационные отчисления
|
39609
|
977,5
|
40586,5
|
|
8. Стоимость
ремонта и ТО средств производства
|
20666
|
630,4
|
21296,4
|
|
9. Стоимость
работ и услуг вспомогательных производств
|
10262,6
|
1800
|
12062,6
|
|
10. Прочие
прямые затраты
|
10755,18
|
452,1
|
11207,3
|
|
11. Затраты на
организацию и управление производством
|
21510,36
|
904,17
|
22414,5
|
|
12. Затраты на
уборку дополнительной продукции
|
-
|
26289
|
26289
|
|
13. Итого
затрат
|
360819,3
|
56526,2
|
417345,5
|
|
14. Затраты
труда на весь объем работ, чел/дн.
|
35,1
|
4,2
|
39,3
|
Полная себестоимость продукции по опыту по
сравнению с контролем увеличивается. Затраты увеличиваются по статьям: оплата
труда на 1406 руб., стоимость ГСМ на 4167., амортизация на 977,5 руб., ремонт и
ТО на 630,4 руб., стоимость услуг на 1800 руб..
В общей сумме затрат по опыту
дополнительные затраты составляют 13,5%.
5.3 Расчет показателей
экономической эффективности яровой пшеницы
Эффективное использование трудовых
ресурсов характеризуется таким показателем как производительность труда.
Производительность труда - это способность
конкретного труда производить в единицу времени определенное количество
продукции (Организация производства…, 2002).
Рентабельность выражается в том, что
предприятие за счет выручки от реализации продукции и услуг покрывает свои
расходы и получает чистый доход, идущий на расширенное воспроизводство и более
полное удовлетворение потребностей трудящихся. Рентабельность характеризует
экономическую эффективность ведения производства.
Чистый доход, или прибыль, представляет
собой разницу между суммой денежной выручки, полученной от реализации
продукции, и полной её себестоимости.
Таблица 5.4.
Экономическая
эффективность возделывания яровой пшеницы и внесения гранулированного
органоминерального удобрения «Пшеничное»
|
№ п/п
|
Показатели
|
Ед. изм
|
Условные
обозначения и формула расчетов
|
Контроль
|
По опыту
|
|
|
1
|
2
|
3
|
4
|
5
|
6
|
|
|
1
|
Площадь посева
|
га
|
П
|
100
|
100
|
|
|
2
|
Урожайность
|
ц/га
|
У
|
15,1
|
26,0
|
|
|
3
|
В т.ч. прибавка
урожайности
|
ц/га
|
У'
|
-
|
10,9
|
|
|
4
|
Валовой сбор
|
ц
|
В=П·У
|
1510
|
2600
|
|
|
5
|
В т.ч.
дополнительный валовой сбор
|
ц
|
В'=П-У'
|
-
|
1090
|
|
|
6
|
Затраты на
производство
|
р.
|
3
|
360819,3
|
432139,6
|
|
|
7
|
В т.ч.
дополнительные затраты
|
р.
|
3'
|
-
|
71320,3
|
|
|
8
|
Себестоимость
1ц продукции
|
р.
|
С=З:В
|
239
|
166,2
|
|
|
9
|
Себестоимость
1ц прибавки
|
р.
|
С'=3': В'
|
-
|
65,43
|
|
|
10
|
Средняя цена
реализации 1ц продукции
|
р.
|
Ц
|
250
|
250
|
|
|
11
|
Стоимость
продукции по ценам реализации
|
р.
|
S=В·Ц
|
377500
|
650000
|
|
12
|
В т.ч.
стоимость дополнительной продукции
|
р.
|
S'=В'·Ц
|
-
|
272500
|
|
13
|
Прибыль (+),
убыток(-)
|
р.
|
Пр = S-З
|
16680,7
|
217860,4
|
|
14
|
В т.ч.
дополнительная прибыль
|
р.
|
П'р = S'-З'
|
-
|
201129,1
|
|
15
|
Уровень
рентабельности производства
|
%
|
Рп = (Пр:3) ·
100
|
4,6
|
50,4
|
|
16
|
Уровень
рентабельности внесения удобрений
|
Рп'=(П'р:3') ·
100
|
-
|
282
|
|
17
|
Окупаемость
затрат
|
р.
|
О= S:3
|
1,05
|
1,5
|
|
18
|
Окупаемость
дополнительных затрат
|
р.
|
О'= S':З'
|
-
|
3,8
|
|
19
|
Затраты труда
|
чел/дн
|
Зт
|
35,1
|
44,5
|
|
20
|
Производительность
труда
|
ц/чел-дн.
|
Птр=В/Зт
|
43,0
|
58,4
|
|
|
|
|
|
|
|
|
В результате применения гранулированных органоминеральных
удобрений прибавка урожайности составила 10,9 ц/га, дополнительный валовый сбор
1090 ц, в связи с увеличением валового сбора производительность труда
увеличилась на 23,2 ц/чел-дн.
Себестоимость 1 ц зерна снизилась на 72,8
руб., себестоимость 1 ц прибавки составляет 65,4 руб..
Таблица 5.5.
Экономическая
эффективность возделывания яровой пшеницы и внесения внекорневой подкормки
«Акварин 5».
|
№ п/п
|
Показатели
|
Ед. изм
|
Условные
обозначения и формула расчетов
|
Контроль
|
По опыту
|
|
|
1
|
Площадь посева
|
га
|
П
|
100
|
100
|
|
|
2
|
Урожайность
|
ц/га
|
У
|
15,1
|
27,8
|
|
|
3
|
В т.ч. прибавка
урожайности
|
ц/га
|
У'
|
-
|
12,7
|
|
|
4
|
Валовой сбор
|
ц
|
В=П·У
|
1510
|
2780
|
|
|
5
|
В т.ч.
дополнительный валовой сбор
|
ц
|
В'=П·У'
|
-
|
1270
|
|
|
6
|
Затраты на
производство
|
р.
|
3
|
360819,3
|
417345,5
|
|
|
7
|
В т.ч.
дополнительные затраты
|
р.
|
3'
|
-
|
56526,2
|
|
|
8
|
Себестоимость
1ц продукции
|
р.
|
С=З:В
|
239
|
150
|
|
|
9
|
Себестоимость
1ц прибавки
|
р.
|
С'=3': В'
|
-
|
44,5
|
|
|
10
|
Средняя цена
реализации 1ц продукции
|
р.
|
Ц
|
250
|
250
|
|
|
11
|
Стоимость
продукции по ценам реализации
|
р.
|
S=В·Ц
|
377500
|
695000
|
|
12
|
В т.ч.
стоимость дополнительной продукции
|
р.
|
S'=В'·Ц
|
-
|
317500
|
|
13
|
Прибыль (+),
убыток(-)
|
р.
|
Пр = S-З
|
16680,7
|
277654,5
|
|
14
|
В т.ч.
дополнительная прибыль
|
р.
|
П'р = S'-З'
|
-
|
260973,8
|
|
15
|
Уровень
рентабельности производства
|
%
|
Рп = (Пр:3) ·
100
|
4,6
|
66,5
|
|
16
|
Уровень
рентабельности внесения подкормки
|
%
|
Рп'=(П'р:3') ·
100
|
-
|
461,7
|
|
17
|
Окупаемость
затрат
|
р.
|
О= S:3
|
1,05
|
1,67
|
|
18
|
Окупаемость
дополнительных затрат
|
р.
|
О'= S':З'
|
-
|
5,6
|
|
19
|
Затраты труда
|
чел/дн
|
Зт
|
35,1
|
39,3
|
|
20
|
Производительность
труда
|
ц/чел-дн.
|
Птр=В/Зт
|
43,0
|
70,7
|
|
|
|
|
|
|
|
|
|
В результате применения «Акварина 5»
прибавка урожайности составила 12,7 ц/га, дополнительный валовый сбор 1270 ц, в
связи с увеличением валового сбора производительность труда увеличилась на 27,7
ц/чел-дн..
Себестоимость 1 ц зерна снизилась на 89
руб., себестоимость 1 ц прибавки составляет 44,5 руб..
Производство на всех вариантах выгодна,
дополнительная прибыль на варианте с органо-минеральными удобрениями составляет
201129,1 руб., на варианте с «Акварином 5» - 260973,8 руб. Уровень рентабельности
по сравнению с контролем увеличился со 4,6% до 50,4% на варианте с
органо-минеральными удобрениями и до 66,5% на подкормки. Уровень рентабельности
означает сколько прибыли будет получено на 100 руб. вложенных средств. Уровень
рентабельности внесения органоминеральных удобрений составляет 282% и подкормки
461,7%.
Все вышесказанное позволяет сделать вывод,
что внесение гранулированного органо-минерального удобрения «Пшеничное» и
внекорневой подкормки «Акварин 5» экономически оправдано.
6. Экологическое состояние природной среды в
районе исследования Атмосферный воздух
В
воздушный бассейн Новосибирской области с выбросами промышленных предприятий и
транспорта поступают тысячи тонн различных вредных веществ. Уровень загрязнения
атмосферы зависит от количественного и качественного состава промышленных
выбросов, их периодичности, высоты, на которой они осуществляются, а также от
климатических условий, определяющих перенос и рассеивание выбросов, от
вымывания вредных веществ атмосферными осадками, от интенсивности
фотохимических реакций в атмосфере и многих других факторов.
По
данным Новосибирского областного комитета государственной статистики выброс
загрязняющих веществ от стационарных источников в атмосферный воздух НСО
составил в 2003г. 206,423 тыс. т.
Качество
приземного слоя атмосферного воздуха городов Новосибирской области, как и
других промышленных центров, определяется суммированием выбросов загрязняющих
веществ от стационарных и передвижных источников и метеоусловий. В последние
годы на качество атмосферы г. Новосибирска все большее влияние оказывают
выбросы автотранспорта.
Районами
с наиболее загрязненной атмосферой на протяжении ряда лет являются
Заельцовский, Кировский, Центральный, Железнодорожный, Ленинский, Дзержинский.
В меньшей степени загрязнена атмосфера Октябрьского, Первомайского,
Калининского и Советского районов города.
Для
города Новосибирска характерно повышенное содержание в приземном слое
атмосферного воздуха взвешенных веществ, диоксида азота (25,952 тыс. т),
формальдегида (17,375 тыс. т), бенз(а)пирена (0,840 т), фенола (43,718 т),
оксидов азота (33,966 тыс. т) и др.
Наибольшее
содержание окиси углерода отмечалось в Советском районе (1,3 ПДК). Более всего
загрязнен диоксидом азота атмосферный воздух Центрального, Железнодорожного,
Заельцовского, Первомайского, Калининского, Ленинского и Кировского районов
города. Максимальная концентрация фенола (3,9 ПДК) в Кировском районе города.
Содержание в атмосферном воздухе фтористого водорода в Ленинском районе города
составила 5,9 ПДК. Средняя концентрация бенз(а)пирена в 2003г. превысила
критерий ВОЗ в 2,9 раза. Среднегодовая концентрация аммиака в целом по городу
Новосибирску отмечалась на уровне среднесуточной предельно допустимой
концентрации. Наблюдения за содержанием сероводорода в атмосферном воздухе
проводятся только в Кировском районе. Максимальная концентрация данной примеси,
зарегистрированная в мае, составила 1,4 ПДК.
Поверхностные
и подземные водыОбщие ресурсы поверхностных вод по
Новосибирской области составляют в среднем 64,3 км3 в год.
На территории г. Новосибирска воды первых
от поверхности водоносных горизонтов четвертичных аллювиальных отложений долины
р. Оби (преимущественно в левобережье) подвержены значительному техногенному
влиянию, в результате которого наблюдается подъем их уровней, тепловое и
химическое загрязнение.
Левобережная часть города подвержена более
интенсивной техногенной нагрузке из-за высокой концентрации здесь промышленных
предприятий, что в сочетании со слабой защищенностью подземных вод создает
здесь неблагоприятную экологическую обстановку. Но относительно высокие
фильтрационные свойства и быстрое обновление аллювиальных водоносных горизонтов
долины р. Оби обусловливают в целом невысокую степень загрязнения подземных вод
за счет эффекта разбавления.
Индекс загрязнения воды р. Тула в 2003г.
Составил 2,05. Вода соответствует 3 классу - умеренно загрязненная. Содержание
фенолов уменьшилась с 4,0 ПДК до 1,0 ПДК. Среднегодовые концентрации составили:
азота нитритного - 2,1 ПДК, азота аммонийного - 3,1 ПДК, нефтепродуктов - 3,6
ПДК, железа - 1,3 ПДК, меди - 14,0 ПДК, ртути - 1,0 ПДК. Кислотный режим
удовлетворительный.
Почвы
Город Новосибирск
занимает площадь более 50 тыс. га.
В результате
промышленных и производственных процессов во внешнюю среду выбрасывается
большое количество отходов, содержащих различные соединения тяжелых металлов,
которые являются токсичными для растений, животных и человека. Особую опасность
представляют загрязнения ртутью, кадмием, свинцом.
Фоновый
уровень тяжелых металлов в биосфере постоянно повышается. Основное количество
тяжелых металлов поступает от предприятий черной и цветной металлургии.
Большими загрязнителями окружающей среды являются ТЭЦ. В последние десятилетия
к названным источникам прибавились предприятия приборостроения, машиностроения,
радиотехники, электроники, химической промышленности.
Анализ
результата обследования почв пробных площадок выявил присутствие в почве
характерных для городов ингредиентов. Концентрация кислоторастворимых форм
тяжелых металлов в сравнении с прошлым годом увеличилась по всем показателям в
1,5-2 раза. Увеличение содержания нефтепродуктов в Кировском р-не со 160 млн1
(2002г.) до 170 млн1 (2003г.). В Ленинском возросла концентрация
водорастворимой формы фтора с 0,75 млн1 до 2,26 млн1.
На
основании проведенных исследований и полученных результатов можно отметить, что
в г. Новосибирске в целом, как и в прошлые годы, наблюдается незначительное
увеличение содержания нефтепродуктов за счет роста интенсивности движения
автотранспорта. Заметно прослеживается тенденция повышения уровня загрязнения
концентрациями кислоторастворимых форм тяжелых металлов в сравнении с прошлыми
годами.
В 2003 году
проведены обследования почв, донных отложений, отобранных на территории
Новосибирской области. Доля обследованной площади полей Новосибирской области
составила 64,9% от общей площади по региону (1414,5 га).
Растительный
мир, в том числе леса
Общая
площадь земель лесного фонда Новосибирской области, составляет 4493,4 тыс. га.
Леса первой группы - 975,1 тыс. га. (21,7 %). Леса второй группы - 212,7 тыс.
га. (4,7 %).
Площадь
покрытых лесной растительностью земель, по сравнению с данными учета лесного
фонда по состоянию на 01.01.2003 г., увеличилась на 3,1 тыс. га, и составляет
2685,2 тыс. га.
Площадь хвойных
насаждений составляет 956,7 тыс. га (35,6 %).
Площадь
мягколиственных насаждений составляет 1709,7 тыс. га (63,7 %).
Общий
запас насаждений составляет 289,65 млн. м3. Запас хвойных насаждений
составляет 116,23 млн. м3 (40,1%). Запас мягколиственных насаждений
составляет 173,23 млн. м3 (59,8%). Площадь лесных культур
увеличилась на 1,4 тыс. га, и составляет 69,6 тыс. га.
Животный
мир, в том числе рыбные ресурсы
Виды животных, занесенные
в Красную книгу Новосибирской области: Серый сурок; Выдра речная; Выхухоль русская;
Северный олень; Марал.
Хищные птицы: Орлан - белохвост;
Стрепет; Беркут; Скопа; Степной орел.
Новые данные о редких и
нуждающихся в охране видах птиц Новосибирской области: Орел - карлик; Осоед
обыкновенный; Сапсан; Филин; Сплюшка; Сычик воробьиный; Кулик - сорока; Черный
аист. Рукокрылые: Водяная ночница; Ночница Брандта; Прудовая ночница;
Рыжая вечерница; Бурый ушан; Северный кожанок.
Таким образом, экологическое состояние
природной среды в районе исследований является умеренно загрязненным. Это с
вязано с большой концентрацией промышленности и автотранспорта.
Выводы и предложения производству
1. Применение органоминерального
удобрения «Пшеничное» увеличило урожайность яровой пшеницы на
66-72%, внекорневой подкормки Акварином 5 - на 84-92%. ОМУ больше влияло на
озерненность колоса, подкормка Акварином 5 на выполненность зерна. Содержание
клейковины в зерне на фоне ОМУ увеличилось на 9%, на фоне Акварина 5 - на 16%
относительно контроля.
2. Применение ОМУ
«Пшеничное» и Акварина 5 было экономически оправданным. На ОМУ себестоимость 1 ц
продукции снизилась на 72 руб. 80 коп., на Акварине 5 - на 89 руб. 00 коп.
Рентабельность на этих вариантах составила соответственно 282% и 461,7%.
3. Органоминеральное удобрение «Пшеничное» с момента
попадания в почву активизировало микробиологические процессы и увеличивало
численность основных групп микроорганизмов в ризосфере растений. Обсемененность
почвы бактериями - аммонификаторами, бактериями, усваивающими минеральный азот,
и микроскопическими грибами в начале вегетации растений возрастала в сравнении
с контролем в 2-3,1 раза, актиномицетов в 2,5-6,8 раза.
. Применение ОМУ «Пшеничное» и Акварина 5
сопровождалось пролонгированным увеличением численности аэробных
азотфиксаторов, аммонификаторов, олигонитрофиллов и высокой активностью
минерализационных процессов в выщелоченном черноземе до момента налива зерна,
что вместе с дополнительным питанием обусловило лучшую реализацию сортового
потенциала урожайности пшеницы.
5. На фоне сложных удобрений в посеве яровой пшеницы
проявился выраженный фитосанитарный эффект в отношении корневых гнилей. На
удобренном фоне культура становилась менее восприимчивой как к семенной, так и
к почвенной инфекции. После применения сложных удобрений снижался запас
почвенной инфекции под следующую вегетацию.
Органо-минеральное
удобрение «Пшеничное» и внекорневая подкормка Акварин 5 являются перспективными
для применения на яровой пшенице в Новосибирской области,
так как позволяют
в производственных условиях увеличить
урожайность зерна и улучшить фитосанитарное состояние почвы.
Список использованной литературы
1. Агрохимия / Б.А. Ягодин, П.М. Смирнов, А.В. Петербурский и
др.; Под ред. Б.А. Ягодина.- 2-е изд., перер. и доп. - М.: Агропромиздат, 1989
- 639с.
2. Агроэкология / В.А.
Черников, Р.М. Алексахин, А.В. Голубев и др.; Под ред. В.А. Черникова, А.И.
Чекереса. - М.: Колос, 2000. - 536с.
3. Адаптивно-ландшафтные
системы земледелия Новосибирской области / РАСХН, Сиб. отд-ние, СибНИИЗХим. -
Новосибирск, 2002. - 388 с.
4. Апаева Н.Н., Свинина О.Г., Шарапова Э.Г., Марьин Т.С.
Комплексное применение агрохимикатов // Защита и карантин растений, 1999. - №8
- С. 24.
5. Аристовская Т.В., Чугунова
М.В. Экспресс-метод определения биологической активности почвы / Т.В.
Аристовская, // Почвоведение. - 1989. - № 11. - С. 142- 147.
6. Артамонова В.С.
Микробиологические особенности антропогенно преобразованных почв Западной
Сибири. - Новосибирск, 2002 - 225 с.
7. Гамзиков Г.П. Азот в
земледелии Западной Сибири. - М.: Наука, 1981. - 267 с.
8. Гамзиков Г.П. Неотложные
задачи по переходу Новосибирской области к устойчивому развитию земледелия //
Сельские новости. - 2000. - № 6. - С. 18-20.
9. Гамзиков Г.П. Агрохимия и
экология длительного систематического применения удобрений в агроценозах //
Почвы - национальное достояние России: Материалы ІV съезда Докучаевского
общества почвоведов: в 2 кн. - Новосибирск: Наука-Центр, 2004. - Кн. 1. - С.
268.
10. Доклад о состоянии
окружающей среды в Новосибирской области в 2003 г. - Новосибирск, 2004 - 232 с.
11. Дурынина Е.П. Сохранение
конидий Н. sativum в почве в зависимости от ее физико-химических
свойств и вносимых минеральных удобрений / Е.П. Дурынина, Т.Б. Чичева, Н.П.
Алексеева // Науч. докл. высш. шк. Биол. науки, 1980. - № 11. - С. 90-95.
12. Звягинцев Д.Г. Почва и
микроорганизмы. - М.: Изд-во МГУ, 1987. - 256 с.
13. Иванов П.К. Яровая
пшеница. - Москва,1954. - 382с.
14. Интенсивная технология
возделывания яровой пшеницы Новосибирской области. - Новосибирск, 1986. - 46с.
15. Кант Гюнтер. Биологическое растениеводство: возможности
биологических агросистем / пер. с нем. Эбель С.О. - М.: Агропромиздат, 1988 -
207 с.
16. Клевенская И.Л.
Микрофлора почв Западной Сибири / И.Л. Клевенская, Н.Н. Наплекова, Н.И.
Гантимурова. - Новосибирск, 1970. - 224 с.
17. Ковальчук А.М. Приемы
подготовки органических и органо-минеральных удобрений и их эффективность на
черноземах Западной Сибири. - Алма-Ата, 1957 - 16 с.
18. Кузнецова Т.Т. Влияние
удобрений на антагонистическую активность микрофлоры к возбудителю обыкновенной
корневой гнили Bipolaris sorokiniana (Sacc.) Shoemaker в ризосфере пшеницы /
Т.Т. Кузнецова, Л.Н. Коробова // Использование микроорганизмов в сельском
хозяйстве и промышленности: Сб. науч. тр. - Новосибирск, 1982. - С. 46-52.
19. Куперман Ф.М. Биологические основы культуры пшеницы. - М.:
МГУ. - 1956. - 277с.
20. Мартынова Г.П., Свинина О.Г., Марьин Г.С., Гущин Ю.М.
Агрохимикаты и фитосанитарное состояние почвы // Защита и карантин растений,
1999. - №10 - 36с.
21. Мерзлая Г.Е., Полунин С.Ф., Гаврилова В.А и др. Органические
удобрения как фактор повышения продуктивности земледелия // Повышение
эффективности удобрений в интенсивном земледелии. - Труды ВИУА. - М.: 1989 - С.
45.
22. Методическое руководство
по агроэкологической оценке земель, проектированию адаптивно-ландшафтных систем
земледелия и агротехнологий. - М.: Агропромиздат, 2005. - 741 с.
23. Минеев В.Г. Агрохимия,
биология и экология почвы / В.Г. Минеев, Е.Х. Ремпе. - М.: Агропромиздат, 1990.
- 206 с.
24. Минеев В.Г. Биологическое
земледелие и минеральные удобрения / В.Г. Минеев, Б. Дебрецени, Т. Мазур. - М.:
Колос, 1993. - 412 с.
25. Мишустин Е.Н.
Микроорганизмы и продуктивность земледелия. - М.: Наука, 1972 - С. 343.
26. Мишустин Е.Н. Ассоциации почвенных микроорганизмов / Е.Н.
Мишустин. - М.: Наука, 1975. - 106 с.
27. Никитаева Н.Н. Влияние
действия и последействия удобрений при их систематическом внесении на урожай и
качество культур севооборота. - Воронеж, 1972 - 19 с.
28. Организация производства и предпринимательства в АПК: Метод.
указания для практических занятий / НГАУ; Сост. Т.А. Чуйкина. - Новосибирск,
2002. - 25 с.
29. Организация производства в сельскохозяйственных предприятиях
/ Под ред. А.А. Никитенко. - 3-е изд., перераб. и дополн. - М.: Агропромиздат,
1985. - 208с.
30. Растениеводство / Под
ред. П.П. Вавилова - Изд. 4-е, доп. и перераб. - М.: Колос, 1979 - 519 с.
31. Рекомендации по
применению удобрений в Сибири / под ред. А.И. Тютюнникова. - Новосибирск, 1978.
- 331 с.
32. Сельскохозяйственная экология: Учебное пособие / Под ред.
А.В. Голубева, Н.А. Мосиенко. - Саратов, 1997. - 418 с.
33. Семендяева Н.В. Региональные особенности почв Новосибирской
области и их сельскохозяйственное использование / Н.В. Семендяева, Л.П.
Галеева, А.Н. Мармулев. - Новосибирск: Новосибирский гос. аграрный ун-т, 2001.
- 128 с.
34. Сорокина Т.А. Влияние
удобрений на микрофлору почвы и ризосферу растений // Использование
микроорганизмов в сельском хозяйстве. - Ленинград, Москва: Сельхозиздат, 1962.
- С. 114-128.
35. Справочник нормативов по сельскому хозяйству. - Новосибирск,
НГАУ, 1998. - 20с.
36. Сэги, Й. Методы почвенной микробиологии / Й. Сэги. - М.:
Колос, 1983. - 295 с.
37. Типовые нормы выработки и расхода топлива на механизированных
работах. - М., 2000.
38. Хацкевич Л.К., Бенкен
А.А. Роль агроэкологических факторов в ограничении почвенной инфекции обычной
корневой гнили пшеницы // Экологические аспекты вредоносности болезней зерновых
культур. - Ленинград, 1987 - С. 27-33.
39. Чекалов К.И.
Приготовление и применение органических и органо-минеральных удобрений. - М.:
Сельхозгиз, 1958 -96 с.
40. Черняева И.И. Роль
биологического фактора в подавлении возбудителя корневой гнили зерновых / И.И.
Черняева, Г.С. Муромцев, Л.Н. Коробова, В.А. Чулкина // Микология и
фитопатология, 1986. - Т. 20. - Вып. 5. - С. 419-424.
41. Чулкина В.А. Корневые гнили
хлебных злаков в Сибири / В.А. Чулкина. - Новосибирск, 1985. - 189 с.
42. Чулкина В.А. Защита
зерновых культур от обыкновенной гнили. - М.: Россельхозиздат, 1979. - 72 с.
43. Чулкина В.А., Чулкин Ю.И.
Управление агроэкосистемами в защите растений. - Новосибирск, 1995. - 202 с.
44. Шевцова Л.К., Сидорина
С.И., Володарская И.В. Изменение качества гумуса почв при длительном
применении удобрений // Вестник сельскохозяйственной науки. - 1988. - № 7. - С.
72-77.
45. Эльмесов А.М., Бесланеев С.М. Применение органоминеральных
удобрений при бессменном посеве кукурузы // Агрохимический вестник - 2002 - № 6
- С. 27.
46. Кucharski Jan. Aktywnosc
drohnoustrojow w glcbach zaliczanych do roznych kompicksow ргzydatnosci
rolniczej nawozonych azotcm mincralnym / Kucharski Jan, Ciccko Zdzistaw,
Nicwolak Tcrecsa // Acta Acad. Agr. ac techn. olsten Agr., 1996. - № 62 - С. 25-35.
47. Schreiber L.R., Green R.J. Effect of root
exudates on Verticillium albo-atrum inhibited by the soil fungi stasis
principles. - Phytopathology. - 1963. - V. 53. - N. 3. - P. 260-264.
Приложение 1.
Зараженность семян яровой пшеницы сорта Новосибирская 29
патогенными грибами перед посевом.